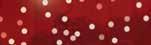

![]()



























































































































Honoring the Past, Building for the Future

By Denise Rolark Barnes WI Publisher
It’s been 60-plus years since the first edition of The Washington Informer was published on October 16, 1964. Much like John B. Russwurm, a journalist, and Samuel E. Cornish, a minister, wrote in the nation’s first Black newspaper, Freedom’s Journal, published on March 16, 1827, Informer founder Dr. Calvin W. Rolark believed that no one else could or should speak for us about the issues of civil rights, human rights, and self-determination for the District of Columbia.
D.C. was a sleepy, predominately Black, yet segregated town when he arrived here in 1952. Like many Black people who migrated to the District from the South during the Great Migration, Dr. Rolark arrived with a vision of a life that would fulfill the promise of freedom, liberty, and opportunity for all.
He received an honorable discharge from the military, where he served in the Korean War. He immediately came to the District rather than returning to his hometown of Texarkana, Texas.
Soon after his arrival, he saw a different D.C. He often spoke of being one of the first Black employees at the Pentagon who worked on the third floor. Black people, allegedly, were usually relegated to jobs performed on one of the two basement levels of the five-side, five-floor above-ground building in Virginia.
He later became a traveling insurance salesman for the Black-owned North Carolina Mutual Life Insurance Company, mostly peddling $.10 insurance policies to Black families in Virginia, North Carolina, and Tennessee. In fact, he first met a young man named Marion S. Barry, as well as the former preacher, lawyer, and civil rights activist and NAACP President Benjamin L. Hooks, while selling insurance in Memphis, Tennessee.
Dr. Rolark also became ensconced in the community of Black business owners and professionals who worked along the U Street and Florida Avenue corridors in Northwest.
He then accepted the managing editor’s job at the Black-owned Washington Observer Newspaper at 9th and Florida Avenue, N.W. He used the opportunity to cover and report on the civic and social activities of D.C.’s growing Black influencers.
While working with members of the U Street Business and Professional Association, he met his first wife, Vera McGlassom, who had come to D.C. from Detroit, Michigan, to work for the federal government. They had one child, me.
about the emerging Black leadership, the changes they were demanding, and how Black people were contributing to improving the quality of life for all D.C. residents.
That became the mission and foundation upon which The Washington Informer was established 60 years ago. And it continues to be our mission today.
Dr. Rolark never believed his newspaper would survive his death. He often referred to his weekly newspaper, which hit the streets every Thursday, as a “weakly” publication.


He also met a lawyer, who later became his second wife, M. Wilhelmina Jackson, originally from Truxton, Virginia, a planned community built for Black people who worked at the Norfolk Naval Shipyard. She came to D.C. to attend Howard University.
In the meantime, Black leaders in D.C. were getting anxious. Congress prohibited D.C. residents from voting, including in U.S. president elections. And the District Commissioners, appointed by the president, were all white, yet overseeing a growing Black population that no longer was willing to settle for the discriminatory policies that controlled their lives and livelihood. It was the growing fight for self-determination that Dr. Rolark joined–and at times, led–that birthed his decision to launch The Washington Informer. Black folks, he strongly believed, needed to be informed of what was taking place politically and economically. Further, white folks needed to be informed
Several Black-owned businesses advertised, including Industrial Bank and Independence Federal Savings & Loan, along with Safeway, Giant, Washington Gas Light Company, Horton’s Funeral Home, and others. But the revenue was never enough to sustain the publication or his family.
Meanwhile, the leaders of a movement that emerged out of the “rebellion” following the assassination of Dr. Martin Luther King, Jr., led to the idea of the creation of a Black fund, a non-profit philanthropic organization that would provide legal and financial support for mostly Black and Brown-led community organizations. Hence, the United Black Fund was established in 1974. That is a story within itself, but in short, it became Dr. Rolark’s passion which he led until he died in 1994.
I, on the other hand, grew up in the journalism business. I received my bachelors degree in journalism, and later a law degree, from HU, “You know!” and returned to The Informer to continue the mission and storytelling that had begun over a decade earlier.
No one can be more grateful than me for what my father left behind. It’s called legacy, and as a second-generation publisher, I can fully relate to the value and benefit to our community that the institutions The Washington Informer and Washington Informer Charities will recognize at our gala on Friday, March 28 at the Martin Luther King Memorial Library.
Ben’s Chili Bowl, Lee’s Flowers and Cards, Industrial Bank, Cheryl A. Lofton Tailoring, Chuck Levin’s Washington Music Center and Stefan Lockridge are institutions and individuals that symbolize legacy and the hard work it takes to maintain and sustain a thriving business in D.C.
It would be difficult to also name the “soldiers with swords” that have helped to sustain The Washington Informer over the past 60, and thankfully, there have been many, from the staff to the advertisers, contractors, and especially the readers, for whom I am sincerely grateful.
But this team we have today is amazing, including my two sons. Hallelujah!
I hope and dream that The Washington Informer will continue beyond the next 60 years. Our voices, your voices, must continue to be heard and amplified for generations to come. We must continue to be the fearless storytellers who will ensure that our history—Black History—will never be erased. That is our legacy.
WI
THE WASHINGTON INFORMER NEWSPAPER (ISSN#0741-9414) is published weekly on each Thursday. Periodicals postage paid at Washington, D.C. and additional mailing offices. News and advertising deadline is Monday prior to publication. Announcements must be received two weeks prior to event. Copyright 2016 by The Washington Informer. All rights reserved. POSTMASTER: Send change of addresses to The Washington Informer, 3117 Martin Luther King, Jr. Ave., S.E. Washington, D.C. 20032. No part of this publication may be reproduced without written permission from the publisher. The Informer Newspaper cannot guarantee the return of photographs. Subscription rates are $55 per year, two years $70. Papers will be received not more than a week after publication. Make checks payable to:
THE WASHINGTON INFORMER 3117 Martin Luther King, Jr. Ave., S.E Washington, D.C. 20032 Phone: 202 561-4100 Fax: 202 574-3785 news@washingtoninformer.com www.washingtoninformer.com
PUBLISHER
Denise Rolark Barnes
STAFF
Micha Green, Managing Editor
Ron Burke, Advertising/Marketing Director
Shevry Lassiter, WIN-TV Producer
Ra-Jah Kelly, Digital Asset Manager
Lafayette Barnes, IV, Editor, WI Bridge DC
Desmond Barnes, WIN Daily Editor
Anthony Tilghman, Social Media Strategist ZebraDesigns.net, Graphic Design
Mable Neville, Bookkeeper
Angie Johnson, Office/Circulation Manager
REPORTERS
Stacy Brown, National Reporter
Sam P.K. Collins, Political/Education Reporter
Zerline Hughes, Housing Reporter
Brenda Siler, Lifestyle Reporter
Lindiwe Vilakazi, Health Reporter
Ed Hill, Sports Reporter
Jada Ingleton, WI Comcast Fellow, WIN Daily
Newsletter Editor
Eden Harris, Reporter
PHOTOGRAPHERS
Shevry Lassiter, Photo Editor
Ja Mon Jackson, Asst. Photo Editor
Roy Lewis, Jr.
Robert R. Roberts
Anthony Tilghman
Abdullah Konte
Cleveland Nelson

INTERNS
Skylar Nelson, Howard University
Tait Manning, Howard University

‘If It is to Be, It is Up to Me’
By James Wright and Micha Green WI Staff Writer and WI Managing Editor
Maurice Fitzgerald was looking through some old papers in his Prince George’s County home recently and came across a program celebrating the 50th anniversary of The Washington Informer.
“I looked at the program and saw pictures of Roy Lewis, Victor Holt and Khalid Naji-Allah, all great photographers of The Washington Informer,” said Fitzgerald, 70, a longtime freelance photographer for the District newspaper. “I said to myself, ‘This is really cool.’ The Washington Informer has come a long way and survived a lot.”
Founded by Dr. Calvin Rolark on October 16, 1964 as a weekly print newspaper, The Washington Informer is celebrating 60 years of publishing news across multiple platforms. Since its inception, the focus of The Informer has been providing positive news of the Black community, something that was often missing from other publications, whether white or Black owned, a point Rolark often stressed.
“The only time there would be anything it would be about robberies, murders, rapes. There would be nothing good about Blacks,” Rolark told The Washington Post in 1988, six years before his death. “They were highlighting the badness, the worst within Black people. I just wanted a paper that would not carry crime.”
Rolark used his resources and network to deliver important news, uplift African Americans and strengthen the District, nation and world.
“In this bi-racial city all citizens should develop awareness of the Negro’s rich heritage and his important role in making ours a great national capital,” Rolark wrote in the first edition of The Washington Informer. “It is our hope, through the pages of The Washington Informer, to bring about better understanding between different ethnic groups through valid and wholesome activities and programs to achieve these purposes.”
One of The Informer’s earliest columnists was former U.S. Rep. Wright Patman (D), a white Texas congressman who wrote weekly about national issues. A native of Texarkana, Texas, Rolark knew Patman through his father, who served as the congressman’s automobile mechanic.
While the paper’s founder was a businessman— as Rolark was a business major at Prairie View A&M in Prairie View, Texas — he founded The Informer in Washington, D.C. for a greater cause than entrepreneurship.
“He started the paper in response to the political events in the city. He wanted to ensure that Black folks in D.C. had a vehicle to express their voices during the Home Rule struggle. There was also increasing violence between D.C. residents and the police,” said Denise Rolark Barnes, current publisher of The Washington Informer and Dr. Rolark’s daughter. So, like all other Black papers—Black publishers, especially—there was a mission that he wanted to pursue.
In addition to the weekly print edition, The Informer has grown to a multimedia outlet, delivering news through the website, newsletters, special editions, social media, WIN-TV,
and its millennial publication WI Bridge.
Beyond news, the publication and Washington Informer Charities have served as a driving force for community gathering and engagement, with: the annual peace walk and parade honoring the Rev. Dr. Martin Luther King Jr., the African American heritage tour every summer, and serving as the official sponsor of the Scripps Spelling Bee in the District and Prince George’s County, Maryland.
“With the activities that it supports, the Informer is dedicated to the Black community,” said Fitzgerald. “The Informer wants to make the community better. Publications like the Informer say that we are a great people and the community comes out to support each other. It is important that we get involved–and not just yell at the T.V.”
While Dr. Rolark died on October 23, 1994, yet his legacy and mission continues. His daughter, Rolark Barnes, immediately became publisher and has been serving in that role for more than 30 years; and his wife, Wilhelmina Rolark, was president of the company before her death on February 14, 2006.
Rolark’s motto, “If it is to be, it is up to me,” continues to serve as a guiding light for The Informer 60 years later.
While she’s been working with the paper since the beginning, as a little girl doing various jobs for the organization, Rolark Barnes doesn’t spend time counting the years. She works hard every day to keep the paper going strong, following news and shifts in media.
“I didn’t really think about how significant [60 years] might be, because we do have so many institutions in this country and all over, even in the Black Press, that are twice as old. But it’s significant because there were so many times when we didn’t think we were going to make it to the next year and we did,” said Rolark Barnes.
The publisher said she is now working to make it beyond March 28, when the company’s 60th anniversary gala takes place at Martin Luther King Jr. Memorial Library
“There’s still some value in what we do, but the next 60 years, I don’t know, I’m going to have to rely on the next generation behind us and the generations behind them to determine where we go from here,” the longtime Informer publisher said. “People ask me, ‘Do we still print a newspaper?’ And I tell them, ‘Yes, we will continue to print The Washington Informer until we can’t. And that decision might not be ours. It may be something that’s happening environmentally… but people still like picking up and reading our publications.”
Fitzgerald said The Informer reminds him of a Black newspaper published during the antebellum period in the United States.
“The Informer is like Frederick Douglass and the North Star, the newspaper he published that fought slavery and fought for
AT 60 Page 5
the rights of Blacks,” he said. “We are part of that. We have to keep it going.”
Winston Chaney, a board operator who worked with Dr. Rolark on his weekly radio show on WYCB-AM 1340, highlighted The Informer’s legacy of reporting positive Black news, accomplishments and achievements over the 60 years and emphasized that it must continue.
“Rolark was brilliant, and he was one of the greatest minds of our time,” said Chaney, 70, who said Rolark’s show ran through the early 1980s until his death in 1994. “He always stressed to me the importance of getting an education. I was glad to call him a friend. I remember closing his show saying,

‘The only people who can save us is us.’”
Chaney, an on-air gospel personality on WHUR-FM, said he was fortunate to have worked with radio hosts like Rolark and Petey Green, a popular District personality known for his street humor and candor about the city’s people and its politics. He said The Informer has been around for decades because it “kept us informed on the issues.”
“The other newspapers, The [Washington] Post and The [Washington] Times, wrote about general issues, but The Informer brought light to what the Black community faced,” he said.
Virginia Ali is the co-founder of the Ben’s Chili Bowl restaurant chain, which is being honored by The Informer at the publication’s celebratory gala on March 28. Ben’s opened in 1958, a year before Dr. Rolark set up a public relations firm, CW Rolark & Associates, in the District after working a few years in Richmond, Virginia.

5 Maurice Fitzgerald has a lot of wonderful memories shooting as a longtime freelance photographer for The Washington Informer. (WI File Photo)
3 Kitty Chaney, Virginia Ali and Sonya Ali read The Washington Informer at Ben’s Chili Bowl. In its 60th year, Virginia Ali says The Washington Informer is an important publication that should keep going. (WI File Photo/ Roy Lewis)
“I met Calvin and Wilhelmina Rolark in the 1960s,” said Ali, 90. “When he set up his newspaper, people were very excited. Black people had another choice when it came to news.”
Having co-founded Ben’s alongside her husband, the establishment’s namesake, Ali said the Rolarks were a prominent political couple in the city. She said
The Informer is “a service to the community and a big asset to Washington, D.C.”
Ali said Ben’s Chili Bowl advertised when it could and helped the newspaper any way it could.
“Throughout the years, The Informer has written articles about us, and we appreciate that,” she said. “Those articles helped us keep our business alive.”
The longtime and celebrated entrepreneur said The Informer is part of a group of noted Black businesses that flourished during the 1960s, before the city became fully integrated.
“Black people had what we needed,” Ali explained, before noting some of The Informer’s 60th gala honorees. “We had Black newspapers like The Informer, Black banks like Industrial and businesses such as Lee’s Flower Shop and others that sustained the Black community.”
Other 60th anniversary gala honorees include Cheryl Lofton of the Lofton Tailors legacy, Adam Levin of Chuck Levin’s Washington Music Center in Wheaton, Maryland and D.C. educator Stefan Lockridge.
Ben’s Chili Bowl celebrated its 75th anniversary in August 2023. As The Informer celebrates its 60th year, Ali expressed confidence that the publication will reach that milestone and continue operating for years to come.
“I would tell The Informer to keep on going,” she said. “They are doing a great job. Denise is doing a great job. She has got it. Her dad taught her well.”
Reflecting on 60 years, Rolark Barnes emphasized that “every day is an achievement for us, because it’s an achievement for Black America.”
“We’re marching forward and we want to document every step of the way,” Rolark Barnes continued. “We just hope to be here with folks as we continue on today to climb that mountain.”
WI
@MichaPGreen / @JamesWrightJr10
By Micha Green WI Managing Editor
The secret to successfully taking over a family business isn’t in one’s last name, genetic makeup, or simply observing operations from the sidelines; it takes passion, determination, closely examining all aspects of the company and years of hard work. Just ask Denise Rolark Barnes, who has spent most of her life working for The Washington Informer and 31 years as publisher, about the necessary commitment and sacrifices it takes to run a family business.
“My dad started the paper when I was 9 years old and [The Informer] is where I spent my summers,” Rolark Barnes said. “And he put me to work.”
“Let’s say I hadn’t been there in a year, at the beginning of that next summer, my job was to write down every ad that was published in the newspaper, the page number, the size of the ad, and how much that ad cost,” she explained.
Even as a young person, Rolark Barnes was efficient in the newsroom, quickly completing assignments allotted to take the majority
of the summer in a few days, and being tasked with a lot of various responsibilities. After ads, she moved on to subscriptions, adding her own youthful innovation to the duty.
“We didn’t have computers then, so the labels for the subscriptions were done on a typewriter. And so my father wanted me to type enough labels for 52 weeks—each one of the subscribers— and that’s when I discovered carbon paper,” she said laughing.
It was during her summers as a little girl at The Informer, then headquartered in downtown D.C., where Rolark Barnes not only learned about operations around the newsroom, but also the importance of engaging with the community, particularly when she made daily treks to the bank to make deposits.
“My trips to the bank normally took about two hours because I knew people,” Rolark Barnes recalled. “And so every day, I’m almost playing a politician. I’m going up and down Seventh Street just saying ‘hi’ to people and having conversations. Those are my earliest memories of working here, probably until I was about 15 or 16.”
However, Rolark Barnes wasn’t set on a professional career with The Informer after secondary school.
”I went to Hampton Institute at the time (now Hampton University) and majored in political science. My plan was to go to law school. I had no plans at all to work for the newspaper,” she said.
Then, she changed her major to mass media, and shortly after, took a close examination of what was happening in the United States and world.
“I realized I needed to be back in D.C. where the heartbeat of the news was taking place,” Rolark Barnes continued. “I came back to Howard University and as a student at Howard School of Communication, was working at the newspaper.”
Through college, Rolark Barnes remained dedicated to The Informer, learning all she could to take back to the publication. She then developed more of her leadership chops in law school.
“I became the editor of Howard University’s law school newspaper and it was at that point when I realized that I really like this business. And so I finished law school in 1980 and started working with my dad at the paper,” she explained.
With Dr. Rolark busy with other responsibilities, as he was also founder of United Black Fund, Rolark Barnes often found herself taking on multiple leadership duties once she began working with The Informer full time. However, she transitioned from supportive daughter and employee to publisher after her father’s death in 1994.
Now 70, Rolark Barnes has helped the weekly publication grow from a three-person staff, with unpaid writers and a strong mission, to a leading multimedia company with a dedicated, talented staff who deliver reliable news daily across multiple platforms.
With more than three decades of publishing under her belt, Rolark Barnes has certainly worked hard to continue and further her father’s mission. She keeps her father’s famous 10 words, “if it is to be, it is up to me,” as a driving force for The Informer.
Celebrating 60 years of publishing, The Informer is a strong source for storytelling and journalism that remains dedicated to its cause of uplifting, educating, empowering and informing African Americans not only in the District, but with digital technology, the nation and world.
“It’s staying true to who we are as a publication that serves the Black community—although all of our readers aren’t Black, but that is our focus and who we cover,” Rolark Barnes said about sustaining a business for decades. “And being able to take all the tools that are available to us and monetize those tools and still find a way to sustain ourselves.”

5 Larry Lee, publisher of the Sacramento Observer, which is celebrating 62 years, with Denise Rolark Barnes, publisher of The Washington Informer at Kitchen + Kocktails in Northwest, D.C. on March 12. (Roy Lewis/The Washington Informer)
Like Rolark Barnes, Larry Lee, publisher of The Sacrament Observer, watched the ins and outs of newspaper publishing throughout his life, with his late father as founder of the now 62-year-old publication.
“My story is not unlike a lot of other publishers except that I literally grew up in the business. The paper is older than I am,’ Lee told The Informer. “And so probably the earliest memories are me being a little kid in the newsroom and the office probably causing mischief. I tended to be a little prankster as a kid.”
While jumping out of corners to scare staff was fun, it was the family time that Lee cherished the most in his early days at The Observer.
“Being around the family is really the thing that probably stands out more than anything, because we really were a family business,” he said. “It’s a place where we all went and had family memories.”
Then, when it was time for post-secondary education, Lee—unlike Rolark Barnes—went to college knowing from the beginning that he would eventually be joining the family business.
“There was a family meeting that my parents had with me when I was about 18,” he said. “They sat me down and asked me if I thought I would be interested in coming back after college to be a

part of the family business. And I naively said ‘yes,’ because I didn’t want to see anything happen to the business.”
This conversation gave Lee purpose. He went to San Jose State to learn all the things he could in order to help his family newsroom continue to thrive post graduation and once he assumed leadership roles.
“I came back in 1997 and worked alongside my parents and officially ascended to publisher in 2015,” Lee told The Informer.
Ten years later, Lee has continued his father’s vision 2023, Lee won Publisher of the Year with the National Newspaper Publishers Association (NNPA).
Lee said he is inspired by Rolark Barnes’ longtime dedication to publishing, having watched and worked closely with her as a fellow member of NNPA and Word in Black— a consortium of 10 Blackowned publications founded during the COVID-19 pandemic and height of Black Lives Matter movement.
Not only does he appreciate the innovative work she’s done with The Informer, but that she’s encouraged the next generation to join the family business, as both of her sons work with the publication and are adding their own visionary leadership.
“Looking at The Informer at 60 years with three generations of veteran leadership within the organization is a tremendous achievement,” he said.
Before Lafayette Barnes IV became publisher of the WI Bridge, he and his younger brother Desmond “DB Bantino” Barnes, were running around the newsroom of The Washington Informer as their mother oversaw daily operations.
“Being born into the paper, initially I started out as, perhaps, a pest around the office,” he said.
Both ever creative to this day, the brothers would transform The Informer’s newsroom from an office space to a fun place.
“I remember balling up pieces of paper and shooting them in trash cans as I ran around the office of The Washington Informer as a young child,” Desmond Barnes, digital newsletter manager, told The Informer.
For the young Barnes boys, it wasn’t all play, they were put to work as well and began to appreciate nuances of the news business.
“I started my first job with The Informer doing deliveries all around the city with a route that took about five hours to finish,” said Desmond Barnes, 37. “Eventually as I grew more skills, I was able to help in other areas such as video editing, social media
and digital marketing.”
In addition to managing the digital newsletters, the younger Barnes brother, who is also a musician and producer, wrote the catchy theme song for The Washington Informer’s video platform WIN-TV.
The older brother also worked his way round the newsroom before starting The Bridge in 2015, which marks a decade this year.
“[I was] gaining interest through basically osmosis— observing the photographers, seeing the cool pictures…. And eventually I started to delve into photography, just in my personal time, and learn about photography through folks at the paper,” the WI Bridge publisher told The Informer. “And then that grew into me freelancing as a photographer and videographer, and throwing events and just creating my own world with the skills that I was learning at the paper.”
Then came time for the eldest Barnes brother to forge his own path with The Bridge, a fun, fresh, millennial publication that is not only informative, but aesthetically pleasing.
The Bridge is more than a publication— it’s a lifestyle brand, hosting sold-out events throughout the nation’s capital, covering happenings internationally and offering information about fashion, influencers and important cultural events in the District.
Having attended Howard University as a marketing major and working for and with companies outside of the family business prepared Barnes to bring back the information he’s learned to The Informer and Bridge.
“The Bridge I think of as like a prototyping spacing for ideas that The Informer might be interested in, or ideas that I have that might need some proof of before I introduce them to The Informer,” the 39-year-old publisher said before touting some of The Bridge’s accomplishments, such as a strong social media strategy and engaging video content.
Barnes IV is proud to be part of The Informer’s 60-year legacy.\
“[The Informer] has created such things as community trust and access. We are an authority when it comes to the Black voice and reaching the entire audience of the DMV- not just African Americans,” he said. “Having 60 years of experience in business, there are so many gems that we’ve been able to collect over time. So it’s been a treat to be able to be exposed to that.”
For the Barnes family, keeping The Informer thriving has truly been an all-hands-on-deck passion and approach. With more than four decades of support for the paper, Lafayette Barnes, Rolark Barnes’ husband and the brothers’ dad, has also been instrumental in connecting The Informer with local and National communities. He is now director of WIN-Africa, a subset of The Informer that covers news across the African Diaspora.
As a longtime publisher, Rolark Barnes has been working to pass down gems to her sons and other staff in hopes of sustaining the business for the next 60 years and beyond.
While there are some things she remains steadfast about, such as printing a hard copy paper until it is impossible to do so, Rolark Barnes looks forward to the evolution of The Informer.
“I am listening to Lafayette, Desmond, and the younger staff in the newsroom,” Rolark Barnes said, “and considering their vision because that’s what will direct us as we move forward.”
Looking ahead, the WI Bridge publisher said he plans to follow the ever-changing trends in news to help keep The Informer thriving for years to come.
“We’re going to continue to do our best to tell the story and represent the communities that we work with. We’re also going to continue to embrace technology and discover the best ways to reach our audience,” Barnes explained. “I hope that for the next 60 years we continue to embrace our community and bring our community into our business more and more.”
WI




Monumental Sports & Entertainment applauds The Washington Informer on its sixty-year legacy of impact and inspiration in the DMV.
As we honor this milestone, Monumental celebrates The Informer’s achievements in raising the game for culture and connection in our city, both for generations past and to come. From one gamechanger to another, congratulations on sixty years of serving D.C.


By James Wright WI Staff Writer
In the nation’s capital, Washingtonians like to look good when they dress up to go to a reception, a political rally or even a community meeting, and Cheryl A. Lofton, the owner of Cheryl A. Lofton Tailoring in Northwest, has helped her customers do just that by altering and improving their suits, jackets and dresses for over three decades.
Tailoring is a part of Lofton’s life and family tradition.
She is the granddaughter of one of the District’s most prominent historical Black businessmen, Joe C. Lofton, the proprietor of Lofton Custom Tailoring, founded in 1939, when the District was racially segregated and African Americans could purchase but not try on clothes at such establishments as Garfinkel’s and Woodward & Lothrop.
She said family members during her era helped their grandfather’s business prosper.
“We grew up in it,” Lofton, 67, told The Informer. “We worked every summer in the family tailor shop. We had the chance to make a little money and learn how to sew and how the business

On March 28, The Washington Informer will celebrate its 60thAnniversary with a gala at the Martin Luther King Jr., Memorial Library in Northwest honoring District legacy Black businesses such as Lofton’s.
“To be honored along with Lee’s Flower Shop, Ben’s Chili Bowl and Industrial Bank is great,” she said. “We are the children of the founders; we grew up together. We continue to run our businesses; we didn’t sell out.”
With the establishment of Lofton Custom Tailoring in 1939, Joe C. Lofton became the first African American to have a tailoring school in conjunction with a business in the District’s downtown.
A self-taught master tailor, throughout the 1940s and 1950s, he earned a reputation as a talented, dedicated entrepreneur offering quality tailoring and alteration services to noted politicians, attorneys, entertainers and other businesspeople.
It has been noted that Lofton’s skills were so highly regarded that he managed to get a contract from the federal government teaching veterans and people with
disabilities how to tailor. This was a major feat as getting a government contract was rare for African Americans for much of the time he operated his business, due to rampant racial discrimination.
“We knew about the government contract but did not dwell on it,” said the younger Lofton, who has taken the lessons she learned from her grandfather as she continues the family legacy. “It was not a big deal. It was a part of our business, a part of what was going on.”
Even though she worked for the business in a limited capacity as a young girl, Lofton joined her grandfather’s business at the age of 12, learning the art of sewing under the tutelage of the master tailor and entrepreneur.
At the age of 18, Lofton started managing one of the two family tailoring shops, working at the establishment while getting a bachelor’s degree from Howard University.
At the shop she managed, she proved herself as a capable tailor providing excellent alterations and custom tailoring to many of the District’s elite.
“One of the most famous people ever to come by was former vice president Spiro Agnew,” said Lofton. “We also tailored for people such as William Raspberry, Ron Walters and Marion Barry. I have a photo of Marion Barry holding one of my infants.”
Lofton explained that her grandfather tailored for musician Fats Domino and some of the musical and theatrical star performers that entertained at the Howard Theatre in Northwest.
With her own business, Lofton has made a name for herself as a person who knows how to fit garments properly on women in the District.
In particular, Lofton is passionate about making sure women’s alterations are performed with every curve of their body in mind.
“While a large part of our clientele continues to be male, I urge women to have a personal tailor to ensure they have a properly fitting garment,” Lofton said.
Historically a family venture, the tailor and entrepreneur said her children are involved in the business, but do not sew.
“They mainly focus on social media and getting the word out about what we are doing,” she said.
As a legacy Black business in the District, Lofton has high hopes for the future of the family business.
“My hope will be that my children and my mentees will continue to carry on the business and pass it along to their childen,” Lofton explained.
She also hopes to change the face of tailoring.
“I don’t have any daughters, but I also don’t want tailoring to always be considered a male dominated profession,” Lofton told The Informer. “That’s why I have two young female assistants, who I mentor, to ensure the presence of a female at the top of my business.” WI
@JamesWrightJr10



By James Wright WI Staff Writer
Ben’s Chili Bowl is considered one of the District’s most iconic restaurants and tourist attractions, with customers ranging from U.S. presidents to high school students sampling its famed half-smokes and other down-home cuisine.
The co-founder of Ben’s, Virginia Ali, is often referred to as a business icon for keeping the establishment she and her husband, Ben Ali, founded in 1958 in a racially segregated Washington on U Street NW, known historically as “Black Broadway” for its variety of theatres and nightclubs. While Virginia Ali has received widespread praise for her stewardship of Ben’s, her role as the matriarch of the Ali family has not been as well known.
Ali, 91, has not only managed to keep Ben’s together and moving forward, but her efforts have also been replicated by her three sons: Sage, Kamal and Nizam.
“My husband and I did not force our sons to work for the business, they wanted to work here,” Ali told The Informer. “We were very surprised they wanted to work. All three wanted to do this. We were very happy about that.”
The Ali brothers will be among the honorees at The Washington Informer’s 60th Anniversary Gala which takes place on March 28 at the Martin Luther King Jr. Memorial Library in Northwest.
“We, the Ali family, are humbled and truly grateful to be recognized by the Washington Informer as you celebrate your 60th anniversary,” said Sage Ali, one of his mother’s three sons. “The Informer has been a meaningful staple in the D.C. community for six decades, and we look forward to another 60 years of you sharing stories that might have gone untold in your absence. Thank you for your dedication, service, and integrity.”

Ben Ali, Virginia’s husband and co-founder of the company, deliberately marked his influence on his son’s lives.
“All three of my sons’ middle name is ‘Ben,’” the matriarch said. “My husband came from Trinidad and the word ‘Junior’ is not part of the culture. So, he gave them different first names, but Ben is their middle name.”
In the early years of its operation, Ben’s often was open late into the night. Virginia Ali explained how she balanced working the long hours the business required and raising a young family.
“I was a very active lady,” she said. “I did not require eight hours of sleep. Working was the natural thing to do.”
The mother and entrepreneur said she would get up in the morning, fix breakfast for her children, and drive them to school.
After seeing her children to school, she came home to prepare for dinner. Then she left for Ben’s, arriving for the 11 a.m. shift.
“I worked and was able to pick up my kids from school every day,” she said.
Virginia Ali said her children worked for the restaurant “when they were big enough to clean off the table.” She said the children received payment and guidance in setting up a savings account and when the time came, a Social Security account. Plus, the couple encouraged saving for college tuition and for things they wanted.
“I remember Sage wanted a minibike,” Virginia Ali said. “We told him he could have one, but he would have to work for it, we were not going to buy him one.”
The mother said her children had chores to do around the house also. But they were allowed to participate in extracurricular activities.
“Kamal participated in basketball, but Sage was into the martial arts,” she said. “Nizam also participated in basketball.”
Virginia said her three grandchildren have not gotten bit by the Ben bug—yet, that is.
“One of my grandchildren is at Syracuse University, another is enrolled at the Savannah College of Art & Design, and another has a master’s degree in film production,” she said. “The one who is in film production told me, ‘Granny, I am not a people person like you.’”
Sage Ali, the oldest of Ben and Virginia Ali’s children, said he cannot remember a time when he was not involved in the business.
“I was always in the business from the time I was tall enough to walk,” said Sage Ali, 64.
“It has been a cornerstone of my life. When I was home from school or during vacations, I worked at the restaurant.”
After high school, the older brother left the District for several years but said he was still involved in the business remotely. He said his present role includes working on the company’s franchising effort.
“All of us do a lot of things,” he said. “We want to keep that sense of family even as we pursue franchising.”
Franchising and building the company’s retail brand is Kamal Ali’s charge as the point man for operations.
“I focus on business growth and development,” Kamal Ali, 62, said. “We are still tweaking our franchising model. We want to make sure that people who want to franchise for us make money for themselves and pay the franchise fee to us. We are also growing our retail brand with 166 Giants carrying our product and some Costcos.”
Nizam Ali, 54, is an attorney with a law license in Maryland but decided to leave the legal profession in 1998 at the 40th anniversary of Ben’s.
“Being trained as a lawyer improved my work ethic and the understanding of how the legal system impacts businesses,” he said. “I like working with the family. It is a challenge, a fun challenge. My brothers and I have healthy debates about where the business should go. We want what is the best for the business.” WI
@JamesWrightJr10

As
(WI File Photo/Ja’Mon Jackson)

By James Wright WI Staff Writer
Ward 3 resident Stacie Lee Banks understands that there are two things that are important in her life—flowers and family. As president and CEO of the District’s Lee’s Flower and Card Shop Inc., she talks often about working every day to ensure the business her grandparents co-founded is flourishing and profitable.
“I enjoy working for the family business,” said Banks, 61, who is often spotted doing various duties at the company’s first brick and mortar, 1026 U Street NW. “It is something new everyday and I enjoy it. Keeping the grandparents’ legacy going is important to me.”
Banks is one of six legacy family businesses who will be honored by The Washington Informer at its 60th Anniversary Gala on March 28 at the Martin Luther King Jr., Memorial Library in Northwest, Washington.
The Lee’s CEO said she appreciates The Informer acknowledging her years of dedicated service as she remains ever-committed to her grandparents’ mission, and works to keep the family legacy going with her own daughter and beyond.

“It makes you feel like your hard work is recognized,” she said. “I am proud to be honored by The Washington Informer.”
Lee’s is a full-service flower shop founded by William and Winnifred Lee in 1945. The business became a staple in the U Street Northwest corridor during the days of the 1940s, 1950s and part of the 1960s— when the street was considered “Black Broadway” in the District.
Throughout the years, Lee’s has survived the 1968 uprising due to the assassination of the Rev. Dr. Martin Luther King Jr.; the exodus of businesses from the corridor shortly afterward followed by the economic decline of the neighborhood; the crack cocaine epidemic of the 1980s; and the building of the Green Line of Metro.
In 1991, the completion of the Metro jumpstarted the revitalization of the immediate neighborhood within the U Street corridor as new businesses and high-end housing started to set up.
Richard Lee, the son of William and Winifred, joined the company in 1968 and served in management until 2012, when he sold it to his daughters, Banks and her sister, Kristie Lee Jones, who serves as the general manager and co-owner.
The sisters are the third generation to run Lee’s.
“When I am not here, I am thinking about the business,” said Banks. “When I was younger, I would want to say to my grandmother, ‘This business is your whole life, I’ll never be like that.’ But now I see it can morph into your life.”
Banks is a native Washingtonian who graduated from McKinley Tech High School in Northeast and studied business management at Howard University. With a passion for serving the community and
keeping the family business thriving, Banks has spent her professional career working for Lee’s, and considers it a labor of love.
Banks’ duties include coordinating the execution of large events, managing vendor relations, overseeing back-of-house operations and representing Lee’s at a variety of public events as the company’s spokesperson.
Banks said business flows because of commercial relationships she has with entities such as Howard University, where the company will often do floral arrangements for Charter Day and graduation exercises, and the Congressional Black Caucus. Lee’s has worked with the Congressional Black Caucus Foundation for years, providing floral and decoration arrangements for its annual gala during the Annual Legislative Conference in September.
“We have made some valuable contracts through the Congressional Black Caucus,” she said.
Banks also belongs to The Links, a professional group of primarily African American women who value community and public service. Her membership in The Links has also generated business for Lee’s.
One of the keys to Banks’ management of Lee’s is her approach to her sister, other family members and employees.
“I have learned to stay in your lane,” she said. “Do what you do best. My sister and I have disagreements, but we have worked together for years, and we are determined to get along.”
Banks has received recognition for her work, including winning the 2018 D.C. Chamber of Commerce Small Business Person of the Year. Additionally, she received national attention when Lee’s received a $10,000 award from Intuit QuickBooks on behalf of its Small Business Council.
“We are extremely grateful to receive this grant,” said Banks in October 2024. “This gift will allow us to expand our resources and pour into our current and future employees with the benefits that they deserve.”
The business has expanded beyond U Street with a location at Union Station in Northeast, D.C.
The Lee’s CEO’s daughter, Samarah Lee Banks, manages the company’s Union Station shop, and said, in a special Mother’s Day edition of The Washington Informer in May 2024, that her mother is an inspiration to her life and career.
“Having an entrepreneur, business owner, boss lady as a mom is really awesome to me, and I aspire to be just like her,” the younger Banks, who has a 1-year-old daughter, told The Informer. “She’s just taught me so much about business — everything I know, honestly, I owe it to her.”
With 48 years of service, James L. Brown is a delivery driver with Lee’s and its longest tenured employee. Having seen the shifts of the business over the decades, Brown is proud of Banks’ leadership and said working with her is a wonderful experience.
“She takes after her grandmother,” said Brown, 67. “She knows how the business should be run. Professionalism is important. You must act professionally, and dress professionally. And she treats the employees like family.”
WI
@JamesWrightJr10



Rodney Oddoye Senior Vice President, Governmental, Regulatory and External Affairs, Pepco Holdings
For over 60 years, The Washington Informer has rved as a voice for the African American community, providing a platform for Black people to tell the compelling stories that shape our lives. Through its commitment to amplify diverse voices, it has become a beacon of advocacy, opportunity, and access. That same commitment to representation drives Pepco’s approach to diversity – not just within the utilities industry, but across every corner of the communities we serve.
As a company with deep roots in the Greater Washington, D.C., region, we know we’re at our best when our teams and workforce reflect the diverse communities we serve. One way to make that a reality is by partnering with organizations that are already doing the work in our communities. We’ve been fortunate to partner with local Historically Black Colleges and Universities (HBCUs), including institutions like Howard University and the University of the District of Columbia (UDC), to connect students with fulfilling, stable career opportunities in the energy sector.
Pepco’s Power Scholars Program provides full tuition and housing scholarships to rising STEM sophomores, along with summer internships, career mentors, peer networking, and additional preparation for full-time, entry-level positions with Pepco. Through our decades-long partnerships with HBCUs, students gain a firsthand understanding of the energy sector’s challenges and opportunities, and they see how their unique perspectives can drive innovation in the future workforce. These programs also build a pipeline of diverse talent – something that is vital for the industry’s growth.
But our commitment doesn’t stop with college students. Together with the District of Columbia’s Department of Employment Services (DOES), Mayor Muriel Bowser, and local contractors, we launched the DC Infrastructure Academy (DCIA), a 14-week program providing paid skills training, certification, and job opportunities for work-ready adults. Now, more than five years later, over 250 graduates have the training and experience needed to pursue good-paying jobs in this high-demand field, putting more Washingtonians on pathways to life-sustaining careers.
Our efforts are about more than filling jobs – true representation matters. When students see people who look like them in leadership roles, they feel empowered to pursue similar paths and believe in their own potential. A more inclusive workforce drives innovation, strengthens communities and economies, and builds a future that works for everyone.
“For over 60 years, The Washington Informer has served as a voice for the African American community, providing a platform for Black people to tell the compelling stories that shape our lives.”
Beyond employment, we’re fostering an inclusive economy by supporting small businesses and diverse-owned startups. The Community Impact Capital Fund expands access to financial resources, helping minority entrepreneurs scale their businesses and reinvest locally. Pepco’s Energizing Small Business Grant Program, managed with woman- and minority-owned platform Hello Alice, provides funding to local small businesses addressing the food desert in northeast Washington, D.C. These initiatives align with our broader goal of working with diverse suppliers, bridging wealth gaps, and creating long-term prosperity in the neighborhoods we serve.
None of this work is possible without strong, collaborative partnerships. We’re proud to work with partners like The Washington Informer who share our vision – championing representation, opening doors to opportunities, and making sure every voice is heard. Together, we can continue moving the needle on diversity, equity, and inclusion, building a future that is stronger, more inclusive, and more prosperous for everyone.





By James Wright WI Staff Writer
Next to discussing and participating in politics, Washingtonians enjoy listening to their musical genres, and Chuck Levin’s Washington Music Center (Chuck Levin’s) in Wheaton, Maryland fuels that love by providing musicians, music groups and other interested organizations and stakeholders with instruments and other tools and materials.
For Adam Levin, the grandson of the co-founders Chuck (for whom the company is named after) and Marge Levin (his wife), the opportunity to lead the family business through the 21st century is a golden one.
“Growing up, I knew the business was around but when I was younger, I wasn’t too involved in it,” Levin, 37, said. “My Dad, uncles and their friends worked for the company. It wasn’t until I got out of college that I began to think about joining the company. I have a thing for the intersection of mathematics and music and was an electrical engineering major at Washington University in St. Louis, which was interesting to me.”

Levin is one of six people identified as a legacy business honoree at The Washington Informer’s 60th Anniversary Gala that will take place on March 28 at the Martin Luther King Jr, Memorial Library in Northwest. Levin said being an honoree is humbling.
“I am surprised and touched deeply,” said Levin. “I am happy that we mean this much to the community. This validates everything we do.”
The company started out in the District at 12th and H Streets NE in 1958 with Chuck and Marge Levin as employees. Former pawn shop entrepreneurs, they dealt with musical instruments and equipment and decided to specialize in that in their new venture.
Their children, Alan, Robert and Abbe, entered the business when they came of age. The establishment developed a reputation for its people-oriented approach to selling musical instruments “from novices who play for fun to professional musicians,” according to an online company statement.
“Chuck knew that musicians didn’t just use their instruments as tools, but in many cases developed an emotional bond with their guitar or tuba or drum kit—you name it,” the statement said.
The Levins decided to move the store out of the District in 1968, because of the uprising due to the assassination of the Rev. Dr. Martin Luther King Jr., when
the store was destroyed due to the violence.
Four months after the uprising, the Levins set up in Wheaton at its present location.
Currently, the company has several buildings that include multiple showrooms, instrument repair workshops, storage facilities and an adjunct business that aids largescale customers with their audiovisual needs.
The company’s namesake led the business until he died in 2002. Then, Marge Levin and her children managed the business until she passed away in 2010.
The younger Levin began working for the business under his father Robert Levin in 2010. However, when his father died in 2013, he formally stepped into lead management.
Having worked for Chuck Levin’s for 42 years, Paul Schein knows the critical contributions the company has made to the DMV community over the decades, and is proud to see the younger Levin continuing his family’s legacy.
“I worked with his grandfather and worked with his father, and he has big shoes to fill,” Schein, 72, said. “When he first came, he had the ‘deer in the headlights’ look but he has the place moving forward. He is large and in charge and he is up to the job.”
Levin said when he joined the company in 2010, he soon learned that what he had observed previously as a youth was “the tip of the iceberg.”
“Working with family is the blessing of my life but there can be some frustrating times,” he said. “I like to say that our family is a functional dysfunctional family. That is, we have remarkable respect for each other despite some disagreements. We come back to the company the next day despite the disagreements.”
Levin has played a significant role in Chuck Levin’s online operations. Customers can now order instruments and pay bills online and the company can order new inventory digitally without the cumbersome paperwork of the past.
Additionally, Levin has created a professional photography studio website so digital customers can see the instruments they are interested in purchasing.
Operating under the title of “general manager,” Levin jokes that the position has him doing a wide variety of activities at the company— from selling equipment, to “sweeping the floor.”
Carlos Romero, who has worked with the company 27 years, emphasized that Levin is managing the family business well.
“I remember seeing Adam as a kid running around the store on his Hot Wheels,” said Romero, 62. “But we knew he was coming. When his dad died, he had to make a quick switch. Adam had to lead it and figure it out.”
WI
@JamesWrightJr10
JPMorganChase is proud to celebrate the Washington Informer’s 60+ years of informing, educating and empowering the Greater Washington community. For more than six decades, the Informer has been a trusted source of news, uplifting voices and sharing stories that matter.

By James Wright WI Staff Writer
The name “Lockridge” in Ward 8 is synonymous with political and civic activism, community engagement and educational advocacy. Now, Stefan Lockridge is working hard to make sure his family’s legacy continues in the future.

“My family business is community activism,” Lockridge told The Informer. “My father and uncle engaged in community activism and so were their spouses. I learned a lot being around them.”
Lockridge is son of the late William O. Lockridge–who served on the D.C. Board of Education as the Ward 8 representative for years until his death in 2011–and Wanda Lockridge, a former chair of the D.C. Democratic State Committee and works in the Office of the Ward 8 Council. Wanda Lockridge served as the chief of staff for then D.C. Ward 8 Council member Trayon White (D) since he took office in 2017, but White was booted off the legislative body earlier this year because of ethics violations and alleged violation of criminal laws.

He is also the nephew of the late R. Calvin Lockridge, a former D.C. School board president.
Lockridge is one of six individuals who will be honored at the 60th Anniversary Gala for The Washington Informer on March 28 at the Martin Luther King Jr. Memorial Li-
“I am super excited to be recognized for selfless service,” Lockridge, 38, said. “I do not go out looking for these things. I love The Informer, and I understand their legacy.
Wanda Lockridge said when her son was young, she and her husband would take him to community meetings with them.
“He didn’t have much of a choice then, he had to go to meetings with me or my husband,” she said. “When he was with me at advisory neighborhood commission meetings, Mary Cuthbert, a colleague, would entertain him.”
The proud mother said when he got older, the younger Lockridge opted out of attending meetings with her, saying “I had enough.” While the interest in direct civic
community activism faded, his passion for supporting residents of neighborhoods east of the Anacostia River did not.
He followed in the footsteps of his father and other kin and pursued a career in education. Lockridge is a graduate of Wilson High School and Middle Tennessee State University in Murfreesboro, Tennessee.
“Music is my thing, particularly music production,” he said. “I wanted to pursue music and stay in the industry and make money.”
The passionate arts educator presently teaches at KIPP DC instructing ninth-12th graders the basics and intricacies of music production and the recording industry. He has been at KIPP for five years, a part of his 17-year career as an educator.
Lockridge said he is undaunted by the negative behavior of some students because he can relate to them in some ways that other educators cannot.
“It is not bad for me. I grew up in a neighborhood that was tough,” he said. “I really have a passion for music. Besides, I was young when I started teaching and not much older than the kids I taught.”
Jacque Patterson serves as a D.C. Board of Education atlarge member and is employed by KIPP as its chief community engagement and growth officer. The politician and leader at KIPP celebrated Lockridge’s work as an educator and in the community.
“Service to the community is in Stefan’s DNA,” said Patterson, 60, in a statement to The Informer. “His parents, the late William Lockridge and mother, Wanda Lockridge, had him at community meetings as a youth. It was ingrained in him and now shows as an educator in the ward and on the board of the William O. Lockridge Community Foundation (WOLCF).”
Continuing his father’s work and legacy, Lockridge serves as vice chair of the foundation named in his father’s honor, with his mother leading the charge as chair.
Founded in 2011 after its namesake’s death, William O. Lockridge Community Foundation is a nonprofit with the mission of supporting the educational goals and aspirations of Ward 7 and 8 students. The foundation offers emergency financial aid, scholarships, and activities such as international travel opportunities to students.
Lockridge said one of his charges with the foundation is to protect the legacy of his father and collaborate with public relations and social media. He said the organization’s staple event “Dancing with the Scholars,” serves as the nonprofit’s primary fundraiser, and he is integrally involved with bringing it to life annually.
“Dancing with the Scholars takes months to plan,” he said, “and I make sure that the audio and visual equipment works to make it a success.”
While she is elated to see her son celebrated by The Informer, Wanda Lockridge is always beaming with pride and in support of her son’s accomplishments.
“I am proud of him,” she said. “He is a third-generation educator. It is so important to have Black men as educators.”
WI @JamesWrightJr10

By James Wright WI Staff Writer
Many people would be apprehensive about following a legacy of such relatives as Jesse Mitchell, the man who revived the District’s only Black financial institution—Industrial Bank—in 1934 after a short period of inactivity. However, his son B. Doyle Mitchell Sr., not only continued his father’s mission, maintaining the bank as one of the largest of its type in the country, but furthered his work, becoming the first Black president of the D.C. Bankers Association.
Now, B. Doyle Mitchell Jr., Mitchell Sr.’s son, has followed in his dad and grandfather’s footsteps, having served as the president and CEO of Industrial since his father’s death in 1993.

Mitchell embraces the work of his forefathers and sees working for Industrial as his way of giving back to the community.
“When I was younger, I saw how we could help people and make money,” Mitchell, 62, said. “You can do well and do good.”
Mitchell is among the six people who will be honored as a legacy business at The Washington Informer’s 60 th Anniversary gala that will take place at the Martin Luther King Jr., Memorial Library on March 28.
Complimenting the grit of Washington Informer Publisher Denise Rolark Barnes, Mitchell said he was flattered to be an honoree.
“Being honored by The Informer is indescribable for a number of reasons,” Mitchell said. “The Washington Informer is a family business. Denise is a colleague, and we are on some boards together. Denise has persevered during some tough times. I have received a lot of awards, but this is among the top five. It is special when you get recognized by one of your homegrown African American businesses. This is super special.”
Mitchell said he has been around the bank since he was a child but didn’t start working there until he was a teenager.
“My sister Patricia started working at the bank when she was 14, but my mother didn’t let me work until I was 16, when I was more mature,” Mitchell said with a giggle. “I started out as a mail messenger. This was when the bank
would send out paper statements to customers. We would send out thousands of paper statements monthly.”
The Industrial Bank CEO said he performed a wide array of tasks for the company.
“I conducted research for the bank, and I worked in bookkeeping, finance, auditing, process mortgage, and when we did those—auto loans— and I worked in operations where thousands of checks are processed each day,” he explained. “I eventually worked in the commercial lending department and as a loan officer.”
A native Washingtonian, Mitchell said he worked for the bank during his summer vacation from Archbishop Carroll High School in Northeast, D.C. He attended Rutgers University, graduating with a bachelor’s degree in economics in 1984.
Mitchell went to work full-time for Industrial full-time after graduation, and in 1990 was elected to the company’s board of directors.
Since assuming the helm at Industrial, Mitchell has helped it maintain its position as the largest minority-owned commercial bank in the Washington metropolitan area and the fourth largest African American owned financial institution in the U.S.
In an August 2010 edition of Washington Life Magazine, writer Adoria Doucette wrote about Mitchell in an article “Power Source: The Mitchell Legacy.”
“The bank is led by the founder’s grandson, B. Doyle Mitchell Jr., who has patiently and expertly guided the institution with the pragmatism of a skilled banker while still intelligently seizing on the opportunity to expand its value to customers and the community,” Doucette said.
“Mr. Mitchell led the bank’s expansion in Prince George’s County In the mid 90’s and at the time was recognized by the U.S. Treasury Department as a pioneer in the industry, cementing the value that his family has played in local development for over seven decades. Heirs of great establishments carry a heavy burden and often flounder where their predecessors flourished, Mr. Mitchell has represented the legacy of his grandfather in an exemplary manner.”
The bank, which celebrated 90 years in August 2024, has seven branches in the District, Prince George’s County, Maryland, two branches in New Jersey and one branch in New York City.
Mitchell serves on several boards, including the Greater Washington DC Black Chamber of Commerce, the National Bankers Association and the Independent Community Bankers of America.
Corey Arnez Griffin, chairman of the Greater Washington DC Black Chamber of Commerce, emphasized that Industrial has supplied the banking needs of Black businesses for decades and praised Mitchell for his leadership.
“Doyle has been a great leader in this town for a long time,” said Griffin, 54. “He has carried on the legacy of his family’s business in a meaningful way.” WI
@JamesWrightJr10
























By Mya Trujillo and Jada Ingleton WI Contributing Writer and WI Digital Equity Fellow
When Dr. Calvin Rolark founded The Washington Informer on October 16, 1964, there was pivotal political and civic action happening for Black people in America and the fight for racial equality.
During the civil rights movement, The Washington Informer became indispensable in preserving and promoting the Black Press’ mission to advocate for Black communities.
“The Washington Informer will be dedicated to news of the total community,” Rolark wrote in the first edition of the publication. “In this bi-racial city all citizens should develop a greater awareness of the Negro’s rich heritage and his important role in making ours a great national capital.”
Founded three months after the Civil Rights Act of 1964, and in business about 10 months when the Voting Rights Act of 1965 was passed, The Informer’s first year was full of critical moments in the U.S. and the fight for equality that shaped the modern Black experience.
Feb. 25: Cassius Clay (later known as Muhammed Ali) wins his first World Heavyweight Championship title after defeating Sonny Liston through a technical knockout after six rounds.
April 13: Sidney Poitier wins the Academy Award for Best Actor for his role in “Lilies of the Field,” making him the first Black man to win an Oscar.
July 2: President Lyndon B. Johnson signs the Civil Rights Act, outlawing public racial discrimination and encouraging integration in public institutions.
Oct. 14: By maintaining a serious commitment to nonviolent resistance against racial discrimination, Martin Luther King Jr. wins the Nobel Peace Prize.
“I accept the Nobel Prize for Peace at a moment when 22 million Negroes of the United States of America are engaged in a creative battle to end the long night of racial injustice. I accept this award on behalf of a civil rights movement which is moving with determination and a majestic scorn for risk and danger to establish a reign of freedom and a rule of justice.” – Martin Luther King Jr.
Oct. 16: Dr. Calvin W. Rolark Sr. establishes The Washington Informer intending to deliver news for Black audiences by Black writers.
“If it is to be it, it is up to me.” – Dr. Calvin W. Rolark Sr.
Nov. 3: Under the jurisdiction of Constitutional Amendment 23, Washingtonians participate in their first presidential election since 1800. While this was a great feat for the city’s residents, Black people across the nation were still not allowed to vote.




Feb. 14: Despite surviving an assassination attempt the night before where his New York City home was blown up, Malcolm X delivers one of his last speeches at Ford Auditorium in Detroit, acknowledging how the struggles faced by Black Americans intertwine with those faced by the global Black community, emphasizing the need for a unified diaspora. His last speech was on Feb. 18 at Barnard College in New York City.
“[Take] our problem out of the civil rights context and place it at the international level of human rights, so that the entire world can have a voice in our struggle. If we keep it at civil rights, then the only place we can turn for allies is within the domestic confines of America.” – Malcolm X, February 14, 1965.
Feb. 21: Shortly after going onstage at the Audubon Ballroom to give a presentation, Malcolm X is killed by three gunmen in front of his wife, Betty Shabazz, and their four daughters. Seen as an attack on the Black community, his assassination was a catalyst for increased racial tensions causing a more militant approach within the Civil Rights Movement.
March Marches: In a series of three marches from Selma to Montgomery, Alabama, the activists protest the systemic restriction of Black Americans’ right to vote during segregation.
March 7: During the first march, led by John Lewis, protesters are met with violence from state troopers on the Edmund Pettus Bridge, often known as Bloody Sunday.
March 9: The second march, led by Martin Luther King Jr., consists of 2,500 people. Under the law of a court order, they turn around after reaching the Pettus Bridge.
March 21-25: With protection from policemen and Army troops, protesters successfully march to Montgomery and present Gov. George Wallace with a petition. On the steps of the capitol building, on March 25, King delivered his famous address: “How Long, Not Long.”
Aug. 6: The Voting Rights Act is passed to eliminate race-related discrimination regarding voting, promising to uphold the Fifteenth Amendment’s assurance that all U.S. citizens are granted the right to vote regardless of race or color.
Aug. 11-16: The Watts Rebellion takes place in southern Los Angeles as a result of police brutality against Black residents and discriminatory regulations regarding housing and employment, catalyzed by the arrest and beating of Marquette Frye. Demonstrators were met with force from the police and the National Guard, and after six days, the Watts neighborhood suffered 34 casualties and more than 1,000 injuries.
Aug. 28: This year marked the 10th anniversary of Emmet Till’s lynching in Mississippi after a white woman, Carolyn Bryant, falsely accused him of flirting with and touching her inappropriately, though decades later she admitted to fabricating her story. Till’s gruesome death opened the nation’s eyes to racially-based violence, propelling the Civil Rights Movement.
In addition, while it did not happen within The Informer’s official first year, there was more progress toward racial equality in 1965.
Dec. 21: The United Nations adopts the International Convention on the Elimination of All Forms of Racial Discrimination– the international law outlining and forbidding racial discrimination and prejudiced policies.
The Informer’s founding came at a crucial time for Black America and continues to create a voice for Black Washingtonians today. The weekly newspaper remains an essential platform as it advocates for racial justice and equity and through news and storytelling, highlights and preserves Black history.
“Our every effort will be directed toward,” Rolark wrote in the October 16, 1964 edition, “raising the economic, cultural and spiritual level of citizens as they fulfill their obligations of first class citizenship.” WI

4A young Denise Rolark sits beside her father, Dr. Calvin Rolark, and stepmother, Wilhelmina J. Rolark, at a spelling bee, an event he helped bring to The Washington Informer to support youth education.



5Marion Barry greets supporters, embodying the charisma and connection to the community that made him a beloved figure in D.C. politics.

5Members of the Washington Bar Association in Resurrection City on the National Mall, after they were dispatched by the National Bar Association to provide free emergency legal assistance to the protesters that participated in the Poor People’s Campaign for civil rights in 1968.
3Coretta Scott King and Dr. Dorothy Height, known as Mothers of the Movement, sit together, each having dedicated her life to advancing civil rights, empowering marginalized communities, and shaping the future of social progress.

5A Black Civil War reenactor, dressed in a Union soldier’s uniform, stands near the Washington Monument, honoring the legacy of Black soldiers who fought for freedom.

5At a 2012 special event, Denise Rolark Barnes interviews John Lewis about his role in the civil rights movement, reflecting on his legacy of creating “good trouble” in the fight equality.
4Maudine R. Cooper, a civil rights advocate and longtime leader of the Greater Washington Urban League, shaped policy in D.C. government and grew the League, advancing economic and social justice.


By Jada Ingleton WI Digital Equity Fellow
Rhonda Lee Thomas was in her 20s when she was first introduced to The Washington Informer through founding publisher Dr. Calvin Rolark, who established the legacy newspaper on October 16, 1964.
After moving to Southeast, D.C., from a contrastingly white Rapid City, South Dakota in the second grade, Thomas developed a knack for equity and social justice that was fueled during her time at the United Black Fund (UBF), a non-profit organization that supported Black-led charitable organizations to improve the lives of Black and impoverished Washingtonians. The non-profit was founded by Calvin and Wilhelmina Rolark in 1969.
“Calvin has been a champion of Southeast when others have not,” LaVerne Gill, then publisher of Metro Chronicle told The Washington Post in 1988, considering his work with UBF and sponsorship of the National Spelling Bee when other papers would not. “To that extent The Informer is a plus.”
Now, as The Washington Informer prepares to commemorate its 60th anniversary on March 28, its storied commitment to inspire, educate and empower the Black community is celebrated among residents, associates, and longtime supporters who consider the paper pivotal to the preservation of African American culture.
Thomas applauds the “class paper” for a generational legacy of stewardship, excellence and truth telling that she says has only catapulted with time under the leadership of current publisher and Rolark’s daughter, Denise Rolark Barnes.
“I’m going to go ahead and say The Washington Informer is the backbone of the Black community. [The Informer] has been here for us,” Thomas stated. “I’m just so happy about the fact that as long as I’ve been here in Washington, D.C., as an adult, as a young woman, it has been here for me.”
One way the award-winning publication has continued its service to Black history is by forging pathways for the next generation of truth-tellers, including offering annual internships and seasonal programs to student and early career journalists.
Fellowships like Chevrolet’s Discover the Unexpected (DTU) have offered aspiring professionals like Juan Benn Jr., an environment to develop the tools and hands-on exposure to propel local storytelling, produce multimedia projects, and understand the realities of the newsroom.
“It’s a very rare experience to get, and I really appreciated [The Informer for] being a part of cultivating young journalists, and giving us a chance to learn and ‘fail’ and try to do things,” said Benn, now an editorial intern at Politico Magazine.
Further, Benn touted the publication’s “particular lens” on Black representation in media, especially in Southeast, the quadrant of the District where The Informer’s office is headquartered on Martin Luther King, Jr. Avenue.
“Stories of Black D.C. aren’t always…highlighted or seen as news, and so for The Washington Informer to step in and do that really important work, it was really inspiring to see that happen in real time,” he told The Informer. “[The Informer] was possibly the smallest news organization I’ve been a part of since I’ve started my journey, but it was probably the most earnest and the most community-based kind of operation.”
Beyond local coverage, The Washington Informer is keen to report national and international news across the African diaspora, and continues to track the storied events that affect Black communities to this day.
Thomas recalls the national news of previous editions, including stories on the rise of Resurrection City and the assassinations of the Rev. Dr. Martin Luther King, Jr., and Malcolm X. She highlighted one of The Informer’s strengths as its ability to inform readers with the principles of journalistic integrity–fairly, accurately, and well.
“The Washington Informer brings all of this to the forefront in a news capacity, without being emotional, without stirring the emotions of the people, and without kissing up,” said Thomas.
This remark comes less than a month after the White House’s historic move to bypass the White House Correspondents’ Association and choose which news outlets are part of the press pool, as well as President Donald Trump restricting the Associated Press access to the White House press room.
Now, more than ever, Thomas said, platforms willing to combat the corruptive ploys to censor the press need to be celebrated.
“The Washington Informer has been a lighthouse for the truth,” she passionately vouched. “We definitely need The Washington Informer, we really need more papers [like it]…that are pro-democracy.”
As an alumni of the Cathy Hughes School of Communication at Howard University, Benn says The Informer “beautifully” exemplifies the foundations of the Black Press established 198 years ago on March 16, 1827.
In addition to fostering partnerships like DTU, The Informer propels the next generation of storytellers by epitomizing the core of Black journalists–to be not just of the people, but truly for the communities in which they serve.
“A part of the tradition of the Black press in general [is to treat] Black people with respect in our storytelling, and that’s something that I really saw in action at The InformSTRONG Page 26



STRONG from Page 24
er,” said Benn, “and it’s something that I want to continue to impart on my own work throughout my entire career.”
For West Virginia native Charlotte Brown, The Washington Informer fulfills a “pivotal” role that all local media should strive towards, especially platforms that represent communities of color.
“With the gentrification and everything that’s been going on in the D.C. metropolitan area, a lot of us…are trying to make sure we can have some understanding of what it means – long-term wise – for our culture,” said Brown. “I think, for me, that’s the way I felt [with The Informer].”
As someone who’s been following The Informer for quite some time, Brown was excited to see the publication’s booth up and running at the 20th Annual MLK Peace Walk & Parade on Jan. 18, another torch passed through generations of the Rolark name.
The celebrated parade – which came into fruition six years before King’s birthday became a federal holiday – is hosted annually by MLK Holiday DC, a committee of individuals and organizations that gather in reverence of King’s life and legacy. Rolark Barnes currently serves as cochair of the committee, while her father and stepmother, Wilhelmina, were two of the co-founding members.
Thomas commends the generational impact and duty to serve others that remains prominent in Washington at the hands of Informer publishers. She notably touts Rolark’s famed motto, ‘If it is to be, it is up to me,’ as a guided principle that has stuck with her throughout her own journey,
both professionally and personally.
“That [saying] has carried me so far in this life, and has helped me to become a person that serves others and wants others to be the best that they can be, and to know that if it’s to be, it’s up to them,” said Thomas, audibly emotional in a phone interview with The Informer.
As Thomas continues to drive change in the community through local activism and partnerships with nonprofits, she maintains her connection with the weekly newspaper by attending local events, keeping a box of favorite editions, and uplifting The Informer’s legacy every chance she gets.
“To my knowledge, there is not another paper in the Washington D.C. area, Maryland and Virginia, that’s as comprehensive, as truthful and as unbiased as The Washington Informer,” Thomas said. “Anything Denise does that I know about, I will definitely support in some kind of way.”
To learn more information about The Washington Informer’s 60th Anniversary Legacy Gala – hosted at the Martin Luther King, Jr., Memorial Library on March 28 – visit WIN60Legacy.com, and prepare to bask in the celebration of stories, minds and empowered voices that continue to mold the future of Black history alongside the treasured publication.
“There’s nothing like [the Black press], really there’s nothing like it,” said Benn. “I’m very grateful for Ms. Denise Rolark Barnes and the entire staff at The Informer. I carry the experience that I had…with me everywhere that I go.”
WI
CONGRATULATIONS TO THE WASHINGTON INFORMER ON 60 YEARS OF SERVING OUR COMMUNITY LABOR DAY WEEKEND | WASHINGTON, DC | AUG 2731, 2025 | BUY TICKETS NOW! 2025 DC JAZZFEST LINEUP
EDDIE PALMIERI AFROCARIBBEAN JAZZ OCTET•BRANFORD MARSALIS QUARTET•LALAH HATHAWAY RON CARTER•THE STRING QUEENS•JOHN SCOFIELD TRIO•THE BAYLOR PROJECT•CECILE MCLORIN SALVANT•EMMET COHEN TRIO•GARY BARTZ NTU TROOP•SUN RA ARKESTRA•KEYON HARROLD CORCORAN HOLT SUPERGROUP FEAT. GEORGE CABLES, STEVE TURRE, SEAN JONES, BILLY HARPER, AND JEFF "TAIN" WATTS•THE JAZZDC ALLSTARS ORCHESTRA DIRECTED BY ALLYN JOHNSON•THE JAZZMEIA HORN QUARTET•MAKOTO OZONE•STEVE WILSON•MATTHEW WHITAKER•BIRCKHEAD•CORCORAN HOLT QUINTET•PAUL CARR QUARTET W/VANESSA RUBIN•CHRISTIE DASHIELL•TONY MARTUCCI EARTH TONES•HIRUY TIRFE QUARTET•AKUA ALLRICH & THE TRIBE•LYLE LINK•HERB SCOTT TODD MARCUS•JONGKUK KIM•LEIGH PILZER•JOSHUA BAYER•ORGAN SUMMIT FEAT. CHARLES COVINGTON•BRASSAHOLICS•DC JAZZPRIX FINALS





Congratulations to the Washington Informer on 60 years of blooming brilliance in community journalism! Like the cherry blossoms that grace our city each spring, your commitment to vibrant storytelling has flourished, enriching our community with every turn of the season.




Learn more about the Festival at NationalCherryBlossomFestival.org






By Brenda C. Siler and Micha Green WI Contributing Writer and WI Managing Editor
As artists are critical to curating worldwide culture, reporting on the arts has been critical to The Washington Informer’s coverage since its inception in 1964.
From partnerships and covering programming at such places like DC Jazz Festival, Arena Stage, The John F. Kennedy Center for the Performing Arts, University of Maryland’s Clarice Smith Performing Arts Center, and Smithsonian Institution, The Washington Informer keeps a major pulse on the creative culture and economy in the District, nation and world.
Throughout DC Jazz Festival’s more than 20 year history, The Washington Informer has been at the forefront, as both a partner and platform, covering some of the major performances, milestones and events.
“We love The Washington Informer as a trusted voice in our community. They have been a DC Jazz Festival partner since day one,” said Sunny Sumter, president and CEO of DC Jazz Festival. “For the past few years, we have offered complimentary tickets for the festival to readers and listeners of WIN-TV. We appreciate the Informer and the WINTV audience.”
In addition to covering performances and event at The Clarice Smith Performing Arts Center, The Informer also


hosts its annual Prince George’s County Spelling Bee in the arts venue on University of Maryland’s campus.
“We at The Clarice Smith Performing Arts Center at the University of Maryland are committed to meaningful partnerships and community engagement,” said Cara Fleck Plewinski, senior director, general management and strategic initiatives at The Clarice. “We value our longstanding collaboration with the Washington Informer, allowing us the opportunity to host the yearly Prince George’s County Spelling Bee. We are honored to provide a space for the
young spellers and their families, and to join The Informer in strengthening ties in our community.”
Throughout Step Afrika!’s more than three decades, The Washington Informer has been present to cover shows, catch up with the company’s leadership, cast and creative team, report on their recent milestone, setting a Guinness World Record for “Largest Stepping Dance.”
Step Afrika!’s Founder and Executive Producer, C. Brian Williams said The Informer plays a critical contribution to storytelling about arts in the nation’s capital and worldwide.
“As Step Afrika! celebrates 30 years of performing all over the world, The Washington Informer has always been there to document, preserve and highlight our work,” Williams said. “From our inaugural performances in Washington, D.C. to Step Afrika!’s successful Guinness World Record attempt at the National Building Museum, The Informer beautifully centers African American achievement and makes sure that our collective efforts are shared widely.”
He emphasized the historic connection between the Black Press and the arts.
“I believe strongly in the relationship between the arts and Black media, and hope to expand on that partnership in the years to come,” Williams told The Informer. “Black media has always played a pivotal role in making sure our stories are told, and helps artists reach a targeted community of patrons and potential supporters.” WI
The DC Housing Finance Agency is a proud and continuous supporter of The Washington Informer. Congratulations on 60 years of informing, educating, and empowering the community. for 60 years of service! The



















Please be a part of history and donate to our legacy.











By Hamil Harris WI Contributing Writer
As a fellow for The Washington Informer through Comcast NBCUniversal’s Digital Equity Local Voices Lab, Jada Ingleton knows and appreciates the value of the 60-year publication’s educational outreach.
A former intern, turned digital equity fellow and soon-to-be staffer, Ingleton, a 2024 graduate of Howard University’s Cathy Hughes School of Communications, said The Informer has not only helped kick start her career, but taught her about the importance of the Black Press.
“Since I’ve had the honor and privilege to serve in the Black Press, I’ve been able to see firsthand the vital role of these publications in telling our stories, championing justice, and shaping generational prosperity in our community,” Ingleton told The Informer.
Covering student achievements, highlighting educators, diving into issues facing schools, partnering with programs, and celebrating changemakers in education has been critical to The Washington Informer’s work throughout the past 60 years.
With partnerships at local high schools and historically Black colleges and universities (HBCUs), plus Washington Informer Charities’ D.C. and Prince George’s County Spelling Bees, the media outlet has not only reported about education, but uplift-
ed it as a key tool toward equity and success.
“The Washington Informer has been an invaluable supporter of our journalism program and key partner for HUNewsService.com,” said Dr. Yanick Rice Lamb, Howard University professor of journalism and editorial director of HUNewsService. com. “No matter what we request, The Informer always comes through — especially [Washington Informer Publisher] Denise Rolark Barnes.”
Moreover, with internship programs and regular educational community engagement efforts, The Washington Informer is dedicated to helping build and prepare the next generation of journalists and media makers.
“Denise and other Informer staff regularly come to campus to speak not only to college students, but also to high schoolers in the Howard University Multicultural Media Academy,” Rice Lamb continued.
Dr. Cherie Ward, director of Archbishop Carroll High School’s Jim Vance Media Program, said The Informer has been a major part of her young journalism students’ formation. With copies of the newspaper to greet anyone who walks through Carroll’s front doors, and Rolark Barnes serving on the media program’s advisory committee, The Informer’s educational outreach has been critical for Ward’s students, particularly in an age of misinformation.
EDUCATION Page 34








By Ed Hill WI Contributing Writer
Whether covering a local high school or college clinching a championship win, standout athlete on the road to stardom, community program, or the recent Commanders comeback season, sports stories are important to The Washington Informer.
Sports are an exciting aspect of culture that allows for thrilling games, offers conversations about health and wellness, highlights history makers and creates opportunities for community outreach and engagement.
As The Informer marks 60 years, local leaders in sports are honoring the publication’s major milestone and celebrating the media outlet’s dedication to sports reporting in the D.C. area and highlighting athletic achievements in Black communities around the nation and worldwide.
Darrell Green, legendary player of the Washington Football Franchise:
“As a 40+ year Washington, D.C./DMV community transplant, I have had the extraordinary privilege of witnessing firsthand the amazing talents of the people behind The Washington Informer!
“On behalf of every athlete (mom, dad, son and daughter) in the region, I would simply like to say how much we all sincerely thank you for the many decades of valuable coverage and responsible storytelling about our hometown teams and the players that we all hold so dear! Absolutely invaluable to us all! Congratulations on 60 years!”
#Forever28
Kenneth Owens, director of athletics for the DC State Athletic Association since 2015:
“The Washington Informer has been instrumental in the coverage of our championships, especially those like chess and ultimate frisbee. It both educates and gives exposure to our non-traditional athletes. It gives exposure that we do not normally get.”
Pigskin Club President William Chesley (involved with the organization since 1990):
“We at the Pigskin Club are grateful for the coverage that The Washington Informer has given over the years. The coverage and support have been important to the work that we are doing,” said Chesley. "The coverage helps in telling our story and continues to make us a viable part of the Washington, D.C. community.”
“The high school programs rank among the best that the nation offers in sports and athletes,” Chesley continued. “There have been numerous coaches and athletes who have gone to be recognized nationally for their achievements, courtesy of The Informer.”
Dr. Alan Chin, who has spent his entire career working with athletes in the District of Columbia Public Schools (DCPS) system as a former coach and director of athletics:
“It’s a credit to Calvin Rolark that he had the vision to provide coverage for the D.C. community. The other newspapers were covering high school sports but as they expanded the coverage, the local sports and programs got less and less coverage. That is where The Informer picked up the slack. It became such a factor that coaches and athletes knew that they would get the coverage. I know that many started scrapbooks to keep the article written in The Informer.”
Chevonne Mansfield, executive senior associate athletics director at Howard University:
“Athletics at Howard has recently experienced as much success as any time in school history. We don’t always get the coverage that we feel we deserve. But The Informer covers a lot of feature stories and profiles that you may not read anywhere else. It gives a special platform for the program. The Informer is definitely a friend to Howard University Athletics.”
Michael Lightfoot, founder of Boot Camp, a physical fitness and health awareness program, celebrating its 20th anniversary, based out of Turkey Thicket Recreation Center in Northeast, D.C.:
“We are so pleased to have the article done on us in The Washington Informer. Since that article, we have had a 10-15% spike in members. But also, we have had some members of the Indian and Turkish communities join. That coverage did as much for the program as we could have imagined. The Informer is a credit to this community.”
Sherita McGill and Sharde Perry, co-founders of Jump DC, winners of last year’s Double Dutch world championships:
“Before the article that The Informer did on us, there were very few people who knew who we were and what we do. The article raised awareness and it’s amazing how we are in demand to display the talents of these young people. It is good to have someone tell these kinds of stories to the community.” WI
EDUCATION from Page 32
“The Washington Informer has been very instrumental in reinforcing the importance of pure journalism based on research and facts,” Ward said. “When Managing Editor Micha Green spoke to students at Archbishop Carroll High School’s Jim Vance Media Program, she provided an opportunity for students to ask questions following her discussion about the principles, practices and techniques of storytelling and how excellent writing skills are the foundation to the profession.”
In addition, The Informer is not just about building up re-
porters, but featuring their work.
“The Informer regularly publishes student work and covers our activities. It has provided internships, jobs, mentors and a home at its offices for students reporting in the field,” Rice Lamb said. “We also collaborated on environmental reporting for Earth Day with a focus on cleanup of the Anacostia River.”
Further, The Informer not only teaches about journalism and legacy of the Black Press, but offers young journalists a deeper understanding of African American history, resilience, strength and D.C. culture.
“I chose to go to an HBCU to expand and deepen my under-
standing of Black culture, and The Informer has only catapulted that growth,” Ingleton said. “The beauty of this experience is you’re ingrained into the city, into an atmosphere that tests who you are as a journalist, and our resilient staff and remarkable leadership has shown me exactly who I aim to be.”
Rice Lamb celebrated The Informer’s contributions as the publication marks six decades of storytelling and community and educational engagement.
“We congratulate The Informer on being a pillar of the community for more than half a century,” she said. “Here’s to another 60 years and more!” WI
It takes dedication, hard work, and a smart and steady approach to help a community thrive. That’s why PNC is proud to celebrate The Washington Informer for all it does to help make our community brilliant. Congratulations on your 60-year anniversary!
By Lindiwe Vilakazi WI Health Reporter
For the past 60 years, The Washington Informer has prioritized covering Black news that educates and uplifts the Black community and beyond.
With several health disparities facing African Americans— from high maternal mortality rates, and challenges with access to health care— The Informer has worked hard to tell important stories that promote overall wellness.
Whether offering health news updates or highlighting wellness experts, care providers and organizations doing work to combat disparities, The Informer is passionate about empowerment through health reporting.
Below are some organizations and health leaders who The Informer has played a critical contribution in reporting about their work and efforts in the Washington metropolitan area and nation.
“On behalf of everyone at Whitman-Walker Health, I am thrilled to congratulate Denise Rolark Barnes and the incredible team at The Washington Informer, for their tireless work to ad-
vance news that matters to all Washingtonians, especially African Americans. Sixty years is a tremendous milestone marked with steadfast, intelligent journalism and activism… celebrating the excellence that exists east of the Anacostia River and highlighting the challenges facing the communities.
“More than 30 years ago, Whitman-Walker Health opened the Max Robinson Center on Martin Luther King Jr. Avenue SE to bring our care and services to the residents of Anacostia. Through the years, we have been with the community – and The Washington Informer – to meet the needs at the moment. Now, in our larger health and research hub in Congress Heights on the St. Elizabeths East campus, we are grateful for The Washington Informer’s commitment to build a stronger and healthier community through outreach and education. We are better when we elevate one another and tell each other’s stories. Thank You.”
Naseema Shafi CEO of Whitman-Walker Health
“At Amerigroup DC, we are committed to strengthening the health and well-being of our communities, and collaborating with The Washington Informer has been instrumental in helping us achieve that mission. As a reliable source of news and informa-
tion for decades, The Informer helps us to connect with D.C. residents, ensuring they are empowered with the information they need to access essential healthcare resources and programs.
“As The Informer celebrates 60 years of impactful storytelling and community engagement, we are honored to support their efforts in serving the people of the District.”
Amerigroup DC CEO and Plan President Adrian Jordan
“We at Howard University College of Dentistry appreciate the longstanding legacy of The Washington Informer, and in ways, are a partner as we both consistently engage our community. The College of Dentistry’s mission is to provide oral health care to improve overall health to the local, national, and global communities.
“Being the fifth oldest Dental School in the United States, and one of two HBCU dental schools, the college plays a vital role in treating underserved communities and populations in the DMV, and The Washington Informer is ever present, sharing valuable information to their audience that is beneficial to everyone.”
Dean of Howard University College of Dentistry Andrea D. Jackson, DDS, MS, FACP, FACD, FICD: WI


By Austin R. Cooper, Jr. and Micha Green WI Contributing Writer and WI Managing Editor
Highlighting challenges, achievements and action across the African Diaspora has been a critical component to The Washington Informer’s coverage.
From reporting about apartheid South Africa and Nelson Mandela’s ascension from political prisoner to president in 1994, to covering the decision to recently oust the South African ambassador to the U.S., The Informer reports about news affecting Black people across the globe.
“The Informer’s mission is to make our world smaller through storytelling and connections -- whether celebrating the emergence of the Free South Africa Movement of the 1980s, to the ongoing travails of Haitian people, to the stories of African immigrants who have otherwise been rendered invisible – the reporting embraces our vision of global solidarity,” said Gwen McKinney, a contributing writer and communications strategist who was instrumental in The Informer covering Mandela’s visit to Washington, D.C. in the early 1990s.
Throughout the years, The Informer has had editors, writers and contributors from across the African Diaspora, as well regular series and columns sharing important international stories such as African and Caribbean News and WIN Africa.
“WIN Africa publishes diverse, informative, and unique stories about the struggles and successes of the African Diaspora,” said Lafayette Barnes Sr., WIN Africa editor. “We are committed to sharing positive news that fosters greater understanding and uplifts all people of African descent, particularly those in the DMV.”

In addition The Informer has been to White House and ventured across land and sea to follow international news such as: the U.S.-Africa Summit in D.C., the United Nations General Assembly in New York, a trip to Sudan in 2004, Abuja, Nigeria in 2006, and Madagascar in 2024.
“In 2004, I traveled on a journalistic delegation to Sudan to bear witness to the humanitarian crisis in Darfur and other parts of the country,” said Rahiel Tesfamariam, author of “Imagine Freedom: Transforming Pain into Political and Spiritual Power,” who then served as The Informer’s editor in chief. “The trip is one example of The Informer’s commitment to Pan-Africanism and covering the African Diaspora.”
Having attended and covered the Leon H. Sullivan Summit VII in Abuja, Nigeria in July 2006, The Washington Informer created a special edition highlighting the historic occasion.
“We so appreciated The Informer’s on-the-ground coverage of the Sullivan Summit in Abuja,” said Hope Sullivan, daughter of
the Rev. Leon Sullivan. “That year, we had a chartered plane of over 200, including the Rev. Jesse Jackson and Martin Luther King III, who joined us in Nigeria. Your coverage of the Summit, including the address by former President Bill Clinton, was amazing. My father also understood and appreciated the role of The Informer and other Black media’s coverage of events in South Africa that resulted in the release of President Nelson Mandela.”
As The Washington Informer celebrates six decades of reporting, the publication’s commitment to global storytelling remains critical.
“Black media plays an important role in keeping our communities informed about what is happening around the world that impacts their everyday lives. It has been particularly relevant in ensuring that we are aware of the many opportunities for us on the African continent,” said the Hon. Linda Thomas-Greenfield, former U.S. Ambassador to the United Nations. “We thank The Informer for their 60 years of reporting about important news across the African Diaspora.”
The Hon. Andrew Young, former U.S. Ambassador to the United Nations and a public figure for close to 70 years, said he recognizes and appreciates the valuable role of Black media in international and domestic news coverage.
“For 60 years, The Washington Informer has played a critical role in keeping its readers abreast of economic, social, and political developments in Africa and the Caribbean,” said Young, who was also former mayor of Atlanta. “Africa is often portrayed negatively in the Western media. To The Informer’s credit, the beauty and potential of Africa are always represented.” WI





The Washington Informer?








By Hamil R. Harris WI Contributing Writer
From coverage, to collaboration and community work, reporting on and partnering with faith leaders have been part of The Washington Informer’s foundation since its founding more than 60 years ago.
For the publication’s founder Dr. Calvin Rolark, it was important that the newspaper not only informed Washingtonians, but also uplifted the Black community and all people.
“Our every effort will be directed toward raising the economic, cultural, and spiritual level of citizens,” Rolark wrote in the first edition of the edition, published October 16, 1964.
Since 1964, we’ve covered moments that have rocked the faith community— from the killing of Malcolm X in 1965, the assassination of the Rev. Dr. Martin Luther King Jr. and subsequent riots in 1968, the Million Man March on The Informer’s 31st anniversary in 1995, and the religious leaders who helped progress the recent Black Lives Matter movement.
As The Washington Informer marks 60 years, local clergy and lay leaders are celebrating the publication’s contributions to not only reporting important religious news, but through coverage uplifting the community as a whole.
The Rev. Donald Robinson, interim pastor of the First Baptist Church of Washington, D.C.


“Congratulations to The Washington Informer for 60 years of uninterrupted service; for being: a beacon of hope, a beacon of service and a beacon of light and information in the D.C., Maryland and Virginia area.
“When I think about The Washington Informer I think about the late Calvin W. Rolark. He used to say, ‘If it is to be, it is up to me.’ He was a guy who promoted Black excellence and Black self determination, economic empowerment. I am

May you keep fighting the "GOOD" fight!
Lawson Street Group is the proud caterer for the 60th Anniversary of The Washington Informer
just glad that his family, particularly his daughter, is carrying the torch. What is really good is that they just don’t do stories; they are really involved in the community.”
The Rev. Tony Lee, pastor of Community of Hope A.M.E. Church
“The Washington Informer is the central voice of our community and the Black Press, especially during this current moment in our history when we see so much of the main press bought out, when MSNBC let people go and so many news organizations are for profit.
“The Washington Informer is our tool and our voice and it is that mechanism that helps us to still be involved in the world. The Informer tells us stories in a way that we can trust. Denise Rolark Barnes is a national jewel who will be written in the anals of history.for continuing the work she has done for her parents as an instrument for freedom and liberation.”
Joyce Garrett, director of Music and Worship Arts at Alfred Street Baptist Church
“You could always depend on The Informer sharing information that you could not find anywhere else about what was going on in our communities. Calvin Rolark was dedicated to that Southeast community way before anybody else was carrying.” PASTORS Page 44


Lawson Street Group is a full service catering and events company that offers a unique and exciting experience for our clients. We are a women and minority owned business, committed to providing the highest quality of food, service, and events. We specialize in global cuisine and events in Maryland, DC and Virginia. We strive to bring our clients a unique culinary experience by creating dishes that are tailored to the individual needs of our clients. Our goal is to make sure that every event we cater is an unforgettable experience.




from Page 42
Imam Talib Shareef of Masjid Muhammad
“The Washington Informer is a Freedom of Speech avenue that was born out of the struggle to see humanity free. It has inherited the hopes, dreams and aspirations of all those produced by this struggle from her parents on down. Today it is a very relevant voice of truth.”
The Rev. Henry P. Davis, pastor of the First Baptist Church of Highland Park:
“The Washington Informer has been critical in terms of getting information out and we always appreciate the willingness for them to cover stories that are particular to our community. We salute The Washington Informer for always being there and to get out a clear message that keeps the community informed to real news.”
The Rev. E. Gail Anderson Holness, pastor of the Adams Inspirational A.M.E.
“The Informer has been the best informer for the African American community in Washington, D.C. and abroad. Scripture says ‘ye shall know the truth and the truth shall set you free,’ and The Informer speaks truth to power.”
The Rev. Mark Thompson, civil rights and leader, podcast host, global digital transformation director for the National Newspaper Publishers Association (NNPA)
“The Washington Informer is very important in the history of Washington and the national African American community. Where would we be without the pioneering work of The Washington Informer and Dr. Calvin W. Rolark? It was important to me as a young man, I had to have a mentor like Dr. Rolark to set me up in places I occupy today. So as far as The Informer goes, so goes me.” WI



By Jada Ingleton WI Digital Equity Fellow
The storied impact of The Washington Informer precedes itself as an impetus to preserve African American culture. Through inclusive reporting and vital collaborations, the publication forges paths for African Americans and unapologetically promotes truth and justice in the retellings of history.
One of these collaborations is touted through Dr. Karsonya “Kaye” Wise Whitehead, president of the Association for the Study of African American Life and History (ASALH), the creators of Black History Month.
“When we’re trying to amplify our Black History Month message, we rely on The Informer to uplift and to center the mission of creating, understanding, teaching and preserving Black history,” said Whitehead. “The Washington Informer has always been one of the many outlets for us, and the hope is that they will continue to do so.”
In the wake of The Informer’s 60th anniversary, and 198 years of the Black Press, the legacy newspaper dons an enduring commitment to supporting the local community beyond weekly print editions and digital uploads.
By partnering with ASALH, The Informer strives to educate and inspire readers with the chronicles of African American leadership. Meanwhile, collaborating with local business owners, and associations like the Greater Washington DC Black Chamber of Commerce (GWBCC), remains key to uplifting the Black trailblazers of today.
Ahead of The Informer’s 60th Anniversary Legacy Gala – which celebrates the notable milestone and six local family businesses –Whitehead applauded the publication for its historic role and ability to emulate the continued relevance of Black-owned media.
She noted that, as a native Washingtonian, she grew up reading several local news outlets and quickly recognized the value of Black storytelling, particularly in the lens of The Informer.
“When we look at how exciting it is that The Washington Informer has been able to do that work over the last 60 years, you’re talking about years of resistance, years through the Civil Rights Movement, years through us working with Black Lives Matter. Years through the building out of the Black middle class that [The Informer] has been there to cover our stories, and to continue to be a firm anchor that is needed when… it feels like the bottom is being washed out from underneath of us,” Whitehead said. “That’s when The Washington Informer is even more important.”
Like Whitehead, Juanita “Busy Bee” Britton, president of BZB International, Inc., knew about The Informer long before the collaborative partnership that has thrived for 30 years.
The entrepreneur became an avid supporter of the paper during the 1980s, and has since spearheaded the role of an instrumental partner, including promoting The Informer amid her own reach and sponsoring the legacy gala on March 28.
“We have got to partner with what’s out there, what’s left that

5Juanita “Busy Bee” Britton (cutting the ribbon) is a longtime supporter of The Informer, having been an avid reader of the publication even before partnering for the last three decades. (Courtesy File Photo)
we’re trying to build and continue to grow even farther,” Britton told The Informer. “It is vital to the [Black] community’s success.”
While The Informer promotes BZB International through advertisements and event coverage, such as the annual ‘Shop Til Ya Drop’ showcase, Britton happily campaigns on behalf of the paper both locally and internationally. The community leader shared that she collects copies of The Informer to take regularly to her village in Ghana, where Britton often leverages the newspapers to enhance literacy and demonstrate the connections of the diaspora.
“They’re reading stories, [and] they’re using them for vision boards. They use the subjects, the titles of the stories, the pictures and the images [The Informer] uses,” Britton said, adding that she also mails print editions to a friend and Washingtonian in Portugal.
“I share the paper with Black people all over the world,” she said proudly.
Whitehead noted that The Informer’s impact as a forcefield for representation is part of what stood out about the publication when she was younger. She recalls her dad, a longtime Informer reader, compelling her with the difference in coverage between local Black media outlets and mainstream publications like The Washington Post.
“It has been the Black Press where…we expect and have been able to get the inner workings of the community, interlocking moments in which our community is able to express more than just terror and pain, but moments of love, laughter, family and community,” Whitehead said. “We look to see our full selves kind of reflected back to us through the Black press.”
ASALH and The Informer work together, amplifying the vision of the Black Press through the annual Black History Month series. Following ASALH’s annual theme each February, The Informer closely centers coverage around African American contributions and achievements, while also highlighting programming, like the organization’s yearly luncheon.
This year, guided in ASALH’s theme “African Americans and Labor,” The Informer produced dozens of stories on Black labor workers, from the barrier breaking efforts of Mary McLeod Bethune and George Washington Carver to the imprint of the first Black labor union, the Brotherhood of Sleeping Car Porters.
According to Whitehead, the “excellent coverage” has dutifully served the ASALH’s mission.
“As we move farther into this particular administration, [the hope] is that the partnership The Informer has played with us in terms of uplifting our message, but also sharing what we’re doing and keeping us informed about what else is happening within the Washington D.C., area…will continue and will grow,” Whitehead told The Informer. “I think we need to rely on one another more now than ever.”
GWBCC Chair Corey Griffin seconds the importance of intersection between Black institutions, notably touting how working with The Informer has been “immensely” beneficial to furthering the mission of the organization founded in 2017.
“The Washington Informer, oftentimes, is the only reputable news outlet where we can have copy on our activities and events, but also we’ve been given the wonderful opportunity to write opeds and contribute our thoughts to issues…whether it be legislative matters or general economic issues, that have an impact to our membership and to Black businesses,” Griffin told The Informer.
An affiliate of the U.S. Chamber of Commerce, GWBCC was established to provide Black businesses with the support that lacked from the DC Chamber, which was once the Negro Chamber of Commerce, according to Griffin.
Now, officially incorporated as of 2019, GWBCC works to increase revenue and growth for Black-owned businesses – like BZB International – across the region.
Through advocacy, education and networking opportunities, the collaborative efforts of The Informer and GWBCC has helped shape entrepreneurial spirit in Washington and continue the fight for equity in corporate America.
“I think it is an inextricable partnership,” Griffin said.
Moreover, he notes the sustainability of these partnerships is vital to the growth of the Black community overall.
“To the extent that we are able to work together, we should do that, and we should be intentional about it,” Griffin told The Informer. “I would say, for Black businesses, really think well about where you spend your dollars, and I would encourage that you look to Washington Informer and other Black press outlets to do your advertising and to support.”
Both Griffin and Britton also lauded Washington Informer Publisher Denise Rolark Barnes for her mutual interests and profound leadership that has not only propelled The Informer forward, but helped do the same for their respective platforms.
Britton said she looks forward to celebrating the legacies of excellence, including Rolark Barnes herself, on March 28.
“We’re just so fortunate to have the strength of The Informer, the push and the tenacity of Denise’s leadership [that] has continued to make this a viable option for us to get our message throughout our community,” Britton told The Informer. “I cannot wait to see her just be applauded by the community at large for all the hard work that she’s done to continue the legacy of her father.”
WI


By Jada Ingleton WI Digital Equity Fellow
Throughout The Washington Informer’s 60-year legacy, the award-winning newspaper has dedicated itself to uplifting the Black community locally and abroad. With Washington Informer (WI) Charities (circa 1989), the media outlet has not only been able to tell stories, but further its mission to create a culture of advocacy, social justice and recognition in the DMV.
“[Dr. Calvin Rolark] always stressed the importance of education and literacy, suggesting that if folks are illiterate, they won’t be able to read his newspaper,” said Washington Informer Publisher Denise Rolark Barnes. “We collaborate with organizations that have a shared mission, and we will be continuing to expand our programs to include digital literacy in the near future.”
Washington Informer Charities, Inc. was established in 1989 to rally, support, educate and nurture marginalized communities. The nonprofit is guided in the missions instilled by Washington Informer founder Dr. Calvin Rolark, who established the legacy newspaper on Oct. 16, 1964.
Coupled with the Black Press, Rolark served an instrumental role in the bounds of literacy advocacy and African American preservation, founding many of the citywide traditions that Washingtonians honor to this day. He started the annual Martin Luther King, Jr. Holiday Parade – established in 1979 and continued through the MLK Holiday DC Committee – and the D.C. Spelling Bee in association with the National Scripps competition.
WI Charities began sponsoring the Prince George’s County Spelling Bee in 2015. This year’s Prince George’s Bee was on March 14 and the District held its 43rd series on March 15, which will stream on DCE Network on April 9.
Now, under the continued leadership of 31-year publisher Rolark Barnes, the combined efforts of The Washington Informer and WI Charities supports these events with sponsored investments, collaborative coverage, and a commitment to driving youth development and empowering generations of African Americans.
“If it’s not for the fact that Calvin Rolark…made sure that this was front and center, we probably would not have drawn the attention nationally that we did [to] create this space,” said Stuart Anderson, co-chair of MLK Holiday DC. “It is still true today that the Black Press is so important–very necessary and needed in telling stories like the life and legacy of Dr. King.”
Anderson said he read about the celebrated MLK Parade & Peace Rally in The Washington Informer for years before he assumed the role of co-chair in 2009.
Conceived in 1977, the parade honoring the life and legacy of the late Rev. Dr. Martin Luther King Jr., began through the collaborative spirits of Dr. Rolark, former Ward 8 Councilmember Wilhelmina J. Rolark, Esq., and radio personality Ralph “Petey” Greene.
The renowned civic leaders fought to honor King’s work fol-
lowing his death on April 4, 1968 and succeeded with the parade’s first commemoration in 1979. Today, committee leaders Anderson and Rolark Barnes work diligently to catapult that mission 46 years later.
“I never thought that I would even be in a room…to pick up the work that they created, and to be able to carry it for 12 years,” Anderson told The Informer. “It’s just wonderful to be able to borrow from them, as they borrowed from others, to move America forward.”
The now coined Annual MLK Peace Walk and Parade has solidified its mark as a staple celebration in the District, regularly bringing out thousands. Past attendees and speakers include former and current public officials, famed musicians, and civil rights legends like the late Dick Gregory, who spoke at the 2014 Peace Walk.
Anderson jokes that he used to have his “own office” at The Washington Informer building in Southeast, adding it was there he felt “propelled” into his role as co-chair, and it was where much of MLK Holiday DC’s movement expanded.
In addition to Informer Charities’ fiscal sponsorship, he applauds the namesake newspaper for its in depth coverage of the annual holiday series, noting the precedent of collaboration and organization among Black institutions to advance Black culture.
“Ten, 20, 30 years from now, people are going to be talking about what Denise Rolark Barnes, Stuart Anderson and our committee have been doing to keep the story and the relevance of the life and legacy of Dr. King alive,” Anderson said. “Who knows what that story will look like if the Informer was not telling it?”
Outside of civil rights leaders, The Washington Informer platform also works to champion Black legacies in neighboring communities. Every summer, WI Charities host the African American Heritage Tour to engage residents in sacred spaces of Black ancestry in the DMV.
“It’s almost like a little known Black history fact,” said Ron Burke, director of marketing and programming at The Washington Informer. “There’s so many places that have African American history in our area that people don’t know about.”
Past tour stops include the historic house and garden of the Tudor Place in Northwest, D.C., where free and enslaved Africans once worked, and landmark cities in Maryland like Annapolis, Baltimore and Boyds, where last year’s group toured the Boyds Negro School–the only public school for African Americans in the Boyds area from 1895-1936.
Moreover, Burke noted, the WI Charities event stands as a bridge to African American empowerment for people of all backgrounds.
“We want to do something to keep our people connected to their culture,” said Burke, “and if they’re from other cultures, to give them some insight into African American culture.”
Further, Washington Informer Charities has established a tradition of championing youth development by annually hosting the citywide and Prince George’s County regional Scripps Spell-
ing Bee tournaments.
Presented by The Washington Informer and Washington Informer Charities, students registered from schools across the District of Columbia and Prince George’s County, leverage the local spelling bees to increase literacy, build confidence, and establish a foundation for lifelong learning.
Retired educator and WI Charities board member, Dr. Elizabeth Primas, let it be known that the continued success of the local tournaments started with Rolark’s leadership as a publisher.
“Let me just say that The Washington Informer has been a beacon for D.C. public schools, and Prince George’s County Public Schools,” Primas said. “Because of [Rolark’s] actions, D.C. got a spelling bee.”
As an avid advocate for youth literacy, Rolark took matters into his own hands back in 1982, when local newspapers denied the nation’s capital a sponsor for the spelling bee, which was further implicated by a rule that prohibited weekly publications – like The Washington Informer – from sponsoring in the local tournament.
Rolark petitioned the National Scripps Spelling Bee to permit weekly newspapers to sponsor, paving the way for African American owned publications to partake in a tradition that represented what many, himself included, stood for.
“Dr. Rolark used to say that, ‘In today’s world, kids will never be able to survive if they don’t know how to read, and they’ll never know how to read if they don’t know how to spell,’” Burke told The Informer. “And so, he took over the spelling bee.”
Now in its 43rd year as a sponsor, and 10th for Prince George’s County, Washington Informer Charities reflects the values of the Rolark tradition and showcases the strength of youth scholars on a local and national platform. The Informer and Primas work together to provide students with spelling coaches and support, while The Informer continuously promotes youth literacy through essay contests, community engagement and inclusive reporting.
Other supportive avenues of the Informer Charities that gauge youth development include financial literacy and supporting high school and college students pursuing careers in journalism.
Primas lauded Rolark as a “groundbreaker,” commending his leadership that opened doors for equity and inclusion in the National Scripps Spelling Bee–for both sponsors and participants. She noted the importance of continuing to uplift scholarship in communities of color, particularly in a crucial time of turmoil for diversity protocols and educational institutions.
“They do not want to acknowledge our excellence. They do not want to acknowledge our potential, and they do not want to acknowledge our contributions,” Primas said, referencing mainstream denial of the Black community. “It’s a must that The Washington Informer and other Black newspapers continue to offer these opportunities for students to show their worth.”
As The Washington Informer prepares its 60th anniversary gala, in which all proceeds will go towards Washington Informer Charities, the charitable board member touted the institution’s enduring legacy of truth, justice and inclusion that each charity event and partnership represents.
“I’m so very proud to be a partner in collaboration with anything that they do,” Primas said. WI

The Washington Informer on 60 years of convening, educating and empowering the greater Washington community as a trusted community voice!
Thank you for being a great partner!














WI Photographers Through the Years:
Lafayette Barnes
Jacques Benovil
Samuel Courtney
John DeFreitas
Maurice Fitzgerald
Jonae Guest

Victor Holt
Ja’Mon Jackson
Dazine Kent
Abdullah J. Konte
Shevry Lassiter
Roy Lewis
Patricia Little
Lateef Mangum
Akmal Muwwakkil
Khalid Naji-Allah
Cleveland Nelson
Marcus Relacion
Travis Riddick
Robert Ridley
Robert R. Roberts
Brigette Squire
Mickey Thompson
Anthony Tilghman
Eric Watson
Lucy Williams
For six decades, the Washington Informer has been promoting positive news about Black communities across the District. They remain dedicated to delivering news that matters, uplifting voices, and fostering connections.
AARP DC is honored to celebrate this milestone and looks forward to working with the Washington Informer to continue this legacy for years to come!




By Sam P.K. Collins and Tait Manning WI Staff Writer and WI Reporting Intern
Richard Wright, a Harlem Renaissance poet, author and essayist, fed his passion for writing as a teenager when he published his first story, titled “The Voodoo of Hell’s Half-Acre” in The Southern Register, a now-defunct Blackowned newspaper based in his home state of Mississippi.
More than a century later, as Black-owned publications and outlets navigate an increasingly digital, multifaceted news media landscape, young journalists like Jamari Tyree remain adamant about telling authentic stories about Black people and eventually launching an independent news venture.
Tyree, 18, has an opportunity to practice her craft at the D.C. public charter school named for Wright.
“It’s important to have that information out [and] Richard Wright Public Charter Schools (PCS) for Journalism and Media taught me.. how to write an article and determine what’s newsworthy while giving me a platform to publish my articles,” said Tyree, who’s currently in her senior year.
In 2021, at the height of the pandemic, Tyree counted among those who started their freshman year at Richard Wright PCS in a virtual academic setting. As she and others gradually made the return to in-person instruction, Tyree continued to explore her professional interests, writing about events and trends on her school campus.
She told The Informer that her portfolio currently includes stories about her experience at the Princeton Summer Journalism Program, Percy “Master P” Miller’s visit to Richard Wright PCS, and an honor that her school’s CEO Dr. Marco Clark received when he accumulated 100 community service hours.
Though she first discovered her love for journalism as a middle schooler following the 2020 presidential election, Tyree acknowledges the students, teachers and staff of Richard Wright as a guiding force and source of encouragement.
“This school has been helpful,” Tyree told The Informer. “It’s always been a welcoming environment, even as a virtual student. Teachers have always been supportive of my interests and done what they could to get me out there as a journalist.”
By the fall, Tyree will most likely be a journalism student at Hampton University in Virginia or North Carolina A&T State University in Greensboro, North Carolina. As high school graduation approaches, she said she remains focused on acquiring the knowledge needed to weigh in on the issues of significance to Black people.
“Normally you don’t really see a lot of Black people on the screen spreading news [but] with me being a D.C. resident, all I know is Black people and Black culture,” Tyree told The Informer. “I want to [pursue journalism] for myself and my generation, especially since people are being silenced when talking about what’s happening in the world.”
Black Press Week, which took place earlier this month, commemorated the 198th anniversary of the founding of Freedom’s Journal, the first Black-owned newspaper on March 16, 1827, published by Samuel Cornish and John B. Russworm. For days, Black newspaper executives, reporters and supporters participated in meetings centered on the Black Press’ nearly 200-year history, and the Trump administration’s all-out war on diversity, equity and inclusion (DEI) initiatives.
The conversation continued days after the Black Press’ 198th birthday, when veteran journalist Hazel Trice Edney held her annual luncheon at the National Press Club, where Black women of various ages and professional backgrounds gave the call for a mass organizing strategy against the latest manifestation of white supremacy.
Trice Edney, a journalist of nearly 40 years, currently operates Trice Edney News Wire, a platform aimed at providing nationally focused, Black-centered news. In terms of what comes next, she said she’s focused on the legions of journalism students she’s taught and continues to educate in Howard University’s (HU) Cathy Hughes School of Communications.
“All of them are great because they’re Howard students, but they come in with one idea of what a Black press story should look like, or a Black story should look like,” Trice Edney, a professor of 16 years, told The Informer as she explained the transformation she sees in her students. “They leave enhanced, because I show them…my portfolio and show them even as they study Black stories in Black newspapers, they are able to see what they should be covering and where we still have holes when it comes to the whiteowned media.”
For more than a third of her tenure at HU, Trice Edney has been teaching a multicultural media history course focused on the history of Black media, which includes Black-owned and operated newspapers, magazines, along with television and radio stations and programs. She said her students received a holistic academic experience, which often included classroom visits by A. Peter Bailey, a veteran journalist and longtime Informer columnist who entered journalism as an editor of The Blacklash, a newsletter for Malcolm X’s Organization of Afro-American Unity.
Another aspect of her Black media history course that Trice Edney mentioned involved her requirement that students bring a copy of a Black-owned newspaper to class and conduct a two-minute presentation about stories they found in the publication.
“It makes no sense for them to spend an entire semester learning about something they have never touched or expe-
FUTURE Page 54




FUTURE from Page 52
rienced,” Trice Edney told The Informer. “That is a major part of their grade and I have never had a student not at least try to do that.”
Trice Edney told The Informer that students go to great lengths to make the grade.
“They bring [newspapers] from across the country and [you would] be amazed at some of the trenches that they find Black newspapers in,” she said. “That’s a good thing.”
For Trice Edney, who’s experience includes stints as a reporter at The Richmond Afro-American and Richmond Free Press, emphasized the role that up-and-coming newsroom professionals have in preserving Black news organizations.
“Young people can join the Black press and not only write for it, but sell advertising for it and fight for it,” she said. “We can all become advocates for the Black Press.”
In the same vein, Trice Edney acknowledged how the second Trump presidency complicates matters a bit.
“[Black newspapers] can’t survive without the advertising dollars,” she said. “[With] the discrimination [that’s] going on, they’re trying to pull out advertising and Black newspapers with the federal government.”
Similar conversations about President Donald J. Trump took place during Black Press Week , which ended with “Black Press Sunday” at Metropolitan AME Church in Northwest, D.C. on March 16. The event was a collaboration between The Informer, Afro-American Newspapers and Washington Association of Black Journalists (WABJ), in commemoration of 198 years of African American publishing and storytelling. In addition, Black Press Sunday served as a celebration of The Informer’s 60th anniversary.
For Phil Lewis, a millennial journalist and WABJ pres-
ident who took part in the Black Press Week festivities, Black-owned and operated news outlets, in this day and age, serve an even greater purpose.
“The Black Press is going to do what it’s always done -- be truth tellers,” said Lewis, during Black Press Week. “Not being swayed by billionaire and capitalist interests. With Jeff Bezos taking over the opinions section of The Washington Post, people trust The Informer, The Afro-American Newspaper, and the Michigan Chronicle.”
Lewis, in his first year as WABJ president, recounted his Black Press experience, particularly moments he spent as a child in Detroit reading issues of The Michigan Chronicle with his grandparents. Decades later, as The Chronicle and other Black Press publications are seeking younger journalists, Lewis continues to play his part as the lead facilitator of WABJ’s Urban Journalism Workshop.
Earlier this month, Lewis and other journalists greeted nearly three dozen D.C. area high schoolers—including the child of an Urban Journalism Workshop alumna— who attended their first session of the spring at American University School of Communication.
Lewis said the overwhelming interest in journalism provides a sense of relief for those concerned about the future of journalism.
“It shows that young people are interested in journalism, in a way where it’s our imperative as mid-career senior journalists to help them come up and learn from us,” Lewis told The Informer. “We need to focus on mentoring more in the spirit of Black Press [because] our community is how we help uplift one another.”
Lewis noted the more than 250 other Black-owned publications under the National Newspaper Publishers Association (NNPA), has and will continue to weather a storm brought on by the extinction of the classifieds section, and exacerbated by stagnant wages and an emphasis on reader engagement rather than quality content.
“When the mainstream media catches a cold, the Black Press has a fever, but we’ve been around due to our community support,” Lewis told The Informer, albeit with a caveat. “The support is invaluable, but it’s true too to say that Black newsrooms are underresourced and that could be a challenge when recruiting and retaining talent.”
In the decades following the emancipation of enslaved Black people, African American-owned publications spurred the Great Migration of the early 20th century. These newspapers also acted as institutions that propelled the fight for school integration, positive Black media portrayal and representation, and mainstream America’s appreciation for African Americans’ contributions.
The Black Press has since faced challenges in the post-civil rights era, especially as Black journalists left Black-owned publications for the supposed greener pastures of the mainstream press. While many news outlets crumbled under the financial pressure, several others that are still in existence often capitulate to moderate, corporate forces that have taken the place of traditionally grassroots funding sources.
While he hadn’t known much about it before college, HU journalism student Amen Debretsion has learned about the history of the Black Press in his multicultural media history
FUTURE Page 56





course. Through the coursework, he has discovered journalists, like Ida B. Wells, who’ve served as models for how to authentically depict the U.S. Black experience.
“I didn’t know journalism had such a big impact on the… development of African-American communities,” said Debretsion, an Oakland resident of Ethiopian descent who’s in his sophomore year at Howard. “Learning about the Black Press really helped me and solidified for me that I have a place in journalism. I can really make an impact.”
As Debretsion recounted, he decided to pursue journalism in high school after watching “The Fourth Estate,” a documentary about The New York Times’ coverage of the first Trump administration. Since enrolling at Howard, Debretsion has joined The Hilltop, where he pens investigative pieces.
He called the experience of writing for an award-winning college newspaper preparation for his ultimate professional goal.
“I want to make an impact [by] making sure that people’s stories don’t go under the radar or some government agenda or journalism institutions twist people’s stories to make it fit the government’s agenda,” Debretsion told The Informer. “I just want to make sure that people’s voices are heard.”
Debretsion said he’s open to carrying out that mission at a Black Press publication.
“I learned a lot more about the power of the Black Press and I feel like [joining a Black-owned newspaper] would just be a better way for me to learn more about our history,” Debretsion told The Informer. “It would be the right place for me to be to make sure I make that change.”
Aniyah Genama, copy-editor and reporter at The Hilltop, said that her involvement in the Black student press has helped her develop a more culturally conscious perspective as a writer.
“There were so many people on campus who were fearful that FAFSA was going to be shut down,” Ford said. “Is it going to happen in the future? We don’t know, but a lot of information is going to be out there and it’s a duty for us to let students know what’s going to impact them so people aren’t in a state of fear at all times.”
“We are held to a very, very high standard at The Hilltop and people are expecting you to come from a Black angle, so that causes you to dig deeper as a Black person and see how these events connect to what we’re going through or what we did go through as a people,” Genama told The Informer. “I think it’s a legacy and responsibility to always keep in mind how this affects Black people and making sure that that connection is clear.”
More than 21 miles north along Baltimore-Washington Parkway, Jayden Ford, co-editor in chief of Spectrum Newspaper at Bowie State University, is using her platform to keep students in the know about how a second Trump presidency will affect their academic careers.
“There were so many people on campus who were fearful that FAFSA was going to be shut down,” Ford said. “Is it going to happen in the future? We don’t know, but a lot of information is going to be out there and it’s a duty for
us to let students know what’s going to impact them so people aren’t in a state of fear at all times.”
In the era where misinformation is increasingly circulating, many young Black journalists like Ford said they feel a sense of responsibility to deliver accurate, honest and culturally relevant news.
“It feels like we’re fighting a war on journalism: there are so many different sources and stories that are being claimed as fake news and being unreliable,” Ford said. “Having a Black Press that Black people are able to rely on, with people who are in their community, has a trust factor that you wouldn’t necessarily get from other publications.”
Black student journalists at primarily white institutions are also working to inform their communities, all the while battling for resources and recognition from their white counterparts.
That’s certainly the case at University of Maryland (UMD) College Park, where the Black student paper, The Black Explosion continues to be a valuable source for information for UMD’s Black student population more than 50 years after its founding.
“Our campus is huge and our Black population here is not small, but the population of Black journalists is small, and that is our audience. They are looking for people that represent them in ways that they can trust.” said Hailey Closson, a staff writer for The Black Explosion and DEI coordinator for The Diamondback, UMD’s main campus student newspaper. “We do need to get those stories out about campus communities. Everything that’s happening isn’t just politics, it’s affecting very real people. The people that are on campus need attention paid to them and we are the people that are going to do it.”
As the Trump administration continues to target DEI initiatives and student political expression, other students, like Jade Tran, who serves as diversion editor for The Diamondback and freelancer for The Black Explosion, said she hopes to combine reporting with elements of activism and pursue further opportunities within Black media.
“I think we’re just in a unique position, especially within this presidency, to be able to speak up about things from a perspective of being affected, and I think getting involved with the Black press is a really good way to have an outlet to do so and reach people.” Tran said. “I would love to be part of something like that and speak freely, but also factually.”
NOTE: The author of this article teaches the multicultural media history class that Amen Debretsion currently takes at Howard University. Debretsion agreed to be interviewed on his own volition, without any promise of extra credit or other rewards. WI
Please be a part of history and donate to our legacy.


By Stacy M. Brown, Jada Ingleton and Micha Green WI Senior Writer, WI Digital Equity Fellow and WI Managing Editor
The collective power of the Black Press starts with a vision set by the founders of Freedom’s Journal 198 years ago: to tell truthful, reliable stories with the goal of positively enriching African Americans and people worldwide.

“We wish to plead our own cause. Too long have others spoken for us,” said John B. Russworm and Samuel E. Cornish, who first published Freedom’s Journal March 16, 1827.
Today, despite President Donald Trump’s elimination of federal diversity, equity and inclusion (DEI) programming and threat to pull funding for teaching parts of African American history (also called critical race theory), The Black Press stands as a trusted and valuable source of journalism and preserving narratives.
“We have to continue ‘to plead our own cause,’ and that cause today includes confronting and challenging the rampant contradictions of the far right who are trying to usher in American fascism,” said Dr. Benjamin F. Chavis Jr., president of the National Newspaper Publishers Association (NNPA), during his “State of the Black Press” address on March 13. “The Black Press of America is needed today more than ever before.”
Often called the Black Press of America, NNPA is a trade organization with 245 print publications and 13 digital and online outlets, all Black-owned.
“There’s no other national news reporting organization that has the local, national, and global reach of the Black Press,” Chavis said in his address, delivered at Howard University’s Louis Stokes Health Sciences Library as part of Black Press Week (March 12-16) celebrations.
With a longtime reputation of highlighting stories of marginalized communities and the change makers often ignored by mainstream media, the Black Press serves as an ever-evolving platform to combat misinformation and preserve history.
Without the Black Press, the characters in the book and movie “Hidden Figures,” highlighting the Black women
who contributed to NASA and the Apollo 11’s moon landing, might still be widely unknown. Margot Lee Shetterly, author of “Hidden Figures: On The American Dream and the Untold Story of the Black Women Mathematicians Who Helped Win the Space Race” used articles from the Pittsburgh Courier, Chicago Defender and 132-year-old Afro-American Newspapers (Afro) in order to dig into these barrier-breaking Black women who worked for NASA.
“This book would not have been possible in the same way without the Black Press, who covered these women, these communities in detail and in full and preserved it for people like me to go back and pick up,” Shetterly told the Afro in 2016, ahead of the release of the celebrated film inspired by her book, starring Janelle Monáe, Octavia Spencer and D.C. native Taraji P. Henson.
Then, there are groups such as the Sylvia Ruth Foundation, an organization that promotes reading and literacy across District of Columbia Public schools, which has been exclusively covered in The Washington Informer.
“The Sylvia Ruth Foundation is dedicated to serving children who do not have access to rich literacy and higher education,” said Stephanie Byrd, a principal, founder of the foundation and daughter of the organization’s namesake. “The Informer has been essential in our efforts to share our work.”
Now, with more than 250 Black-owned publications in NNPA, the Black Press has no plans of slowing down and still wishes to deliver diverse news that promotes equity, inclusion and justice for all.
“In an era when our stories are often marginalized or overlooked, the Black Press remains an essential resource amplifying the voices and experiences of Black individuals and communities across the nation,” said NNPA Fund Chair Karen Carter Richards.
In his “State of the Black Press” address on March 13, Chavis did not mince words in addressing the urgency of the times, while also looking to the future.
He warned of the condescending weaponization of terms like “high and woke” to incite fear, hatred, and social regression, emphasizing that the Black Press must remain steadfast in combating misinformation and right-wing efforts to dismantle democracy.
Chavis, a longtime civil rights activist, author and faith leader, rejected the narrative of “fake news”and “alternative truths,” pledging that Black-owned media would persist in exposing lies and amplifying the voices of Black communities nationwide.


“My daddy did not do this for me to shrink and say, ‘Oh woe is me.’ I’ve been through some hard times with this newspaper,” she said, before emphasizing she’s up to tackle any obstacle that tries to get in the way of her work and mission. “It has been tough. Bring it on.”
BLACK PRESS from Page 58
Beyond reporting, he stressed that Black media’s role extends to influence and advocacy, describing it as “a syndicate, a collaboration, and a togetherness of not only the production of news but its distribution and its impact.”
While the Black Press has immediate plans such as “targeting Target”— supporting and covering national boycotts of the company after it reneged on its pledge to DEI funding and programming— the work doesn’t end at financial boycotts.
The ultimate goal is true freedom and overall equity.
“We just can’t react to oppression,” Chavis said during his address. “We need to be planning our liberation, planning our progress, planning our advancement as a people.”
Speaking at the Trice Edney News Wire Stateswomen for Justice Luncheon at the National Press Club on March 19, Washington Informer Publisher Denise Rolark Barnes emphasized that the Black Press is a valuable platform for uniting and furthering efforts to combat discrimination and uplift justice.
Although advertising dollars might be diminishing in the age of DEI cutbacks and rising tariffs, and while journalists have faced attacks from the Trump administration for their unwillingness to deny truths, Rolark Barnes said she is prepared for the work ahead.
Encouraging the crowd to do their parts to effect change, she explained taking action includes mobilization, supporting Black-owned businesses, engaging in efforts to uplift the entire African Diaspora and promoting positive narratives, just as she does as publisher of The Washington Informer.
”I’m not fearful. I am excited. I am determined. I’m ready for the fight,” said Rolark Barnes, whose father founded The Informer in October 1964.
As the publication commemorates 60 years of publishing, overcoming obstacles, growing and thriving, Rolark Barnes said she is inspired by the strength and resilience of her ancestors and motivated to further the legacy of The Informer and Black Press as a whole.
“My daddy did not do this for me to shrink and say, ‘Oh woe is me.’ I’ve been through some hard times with this newspaper,” she said, before emphasizing she’s up to tackle any obstacle that tries to get in the way of her work and mission. “It has been tough. Bring it on.”
WI


Since 1964, The Washington Informer has been a powerful voice for the Black community - informing, inspiring, and empowering with news that matters. Their dedication to positive and comprehensive storytelling has strengthened businesses, uplifted communities, and fostered change.
At Signarama Silver Spring & DC North, we are especially grateful for their unwavering support in promoting our business. It has been an honor to collaborate with them on impactful signage projects over the years.
Congratulations on 60 years of excellence! Here’s to many more!


By Jada Ingleton WI Digital Equity Fellow
From faith based press conferences, to the inaugural Black Press Sunday service at Metropolitan A.M.E. Church on March 16, faith leaders, activists and members of African American media have risen in unison to once more heed the call for civil rights and to champion justice.
“We serve a God who commands us to speak for those who cannot speak for themselves. We are called to be truth tellers, justice seekers and hope bearers in a world that often seeks to silence us,” said Washington Informer Publisher Denise Rolark Barnes during the Sunday service at Metropolitan, held on the official anniversary of the founding Black Press. “Today, as we reflect on our legacy, let us be reminded that our work is not separate from our faith.”
Throughout the last several weeks, passionate voices and motivational sermons from press leaders and faith activists have worked to uplift institutional values and restore faith in the Black community.
“The only question we should be asking ourselves right now [is], ‘What’s our resistance?’” said spiritual advisor and faith leader Dr. Barbara Williams-Skinner on Feb. 17, during a Presidents Day press conference, also at Metropolitan A.M.E.
During the Feb. 17 press conference, gathering members of the media to relay the message, there was one common notion: it’s time for organized action, and the Black church is ready to lead the charge.
“We have everything we need to fight,” Williams-Skinner continued. “We don’t need to do anything, but get enough backbone to believe that if God is with us, who can be against us.”
Black Press Sunday speakers like Rolark Barnes and guest preacher Dr. Ravi K. Perry took to the pulpit with marching orders for the press and all people in order to further the justice movement.
The Rev. William Lamar IV, pastor of Metropolitan A.M.E., lauded the enduring legacy of the Black press in a heartfelt message during the commemoration.
“I want to remind us today that the same love that the Black Press used from 1870 to 1930, when mothers and fathers and children had not seen one another, when enslavement pulled us apart—you can find the ads in these papers,” Lamar told the congregation on March 16, noting that the Black Press was a key tool to reuniting families post the abolition of slavery. “Their work is rooted in love for us and love for people, and we must support them.”
The inaugural service culminating Black Press Week (March 12-16), was a perfect opportunity to emphasize the deep-rooted intersection between the church and African American storytellers.
Rolark Barnes highlighted that the first African American owned newspaper – Freedom’s Journal – was established in 1827 by a journalist, John B. Russwurm, and a faith leader, the Rev. Samuel E. Cornish.
Further, Rolark Barnes noted that author, abolitionist and freedom fighter Frederick Douglass – a trailblazer of the Black Press with his publication The North Star – was a former member of the
historic Metropolitan A.M.E.
“Just as the Black church has been our refuge and foundation, the Black Press will continue to be our mirror, our megaphone and our movement,” said Rolark Barnes.
During his sermon, Perry commended the work of the Black Press as the spirit of the “anointing,” which he explained is another word for fulfilling God’s true calling.
The political scholar encouraged the room of journalists, religious leaders and allies to continue to seek faith to fulfill their “divine purpose” ordained by God.
“Anointing is not a momentary, singular act. It is a task, indeed a charge we keep,” Perry preached. “It is a responsibility we have to fulfill. It’s our opportunity to be more like Jesus right here and right now in our lives.”
Perry also emphasized the power of turning to faith in times of distress, noting the stories of injustice and resilience lamented in the Bible.
“Jesus and (Chapter) Isaiah remind us that our faith, our purpose, our fast, is to be for the upliftment of those unhoused, those left behind, the broken, the dispirited, the oppressed, and by truly activating our faith, by being productive citizens, we too will be blessed,” Perry said. “God simply asked, let us do justice. So yes, I will sing praises. I will fight.”
For the Rev. Dr. Carlton Waterhouse, an ordained elder at Metropolitan A.M.E, part of the fight is amplifying the combined mission of the Black Press and church.
After attending Black Press Sunday, Waterhouse revealed he was moved by the critical role of Black publications in “the struggle for African American freedom.” He further noted the opportunities at large to enhance the movement such as: op-ed collaborations, strategic meetings, and building readership through members of the church.
“Things are developed through Black media, along with Christian communities that are committed to social justice–where people network, organize and strategize on ways to improve our situation, and the situation for all people who are in need,” Waterhouse told The Informer.
Just three days before the March 16 service, the Rev. Dr. Benjamin F. Chavis Jr., president of the National Newspaper Publishers Association (NNPA), delivered the “State of the Black Press” at Black Press Day on March 13, hosted at Louis Stokes Health Sciences Library in Northwest, D.C.
In his call to action to the 258 publications part of NNPA, he reiterated the purpose of the Black Press, as well as the necessity to return to the foundations of faith.
“From the very beginning of the Black Press, we have been a praying people, a singing people, a unifying people,” Chavis said. “We need a Black church-Black press revival.”
In this age of eliminating federal diversity, equity and inclusion programming, and executive orders that challenge equity and racial progress, faith leaders and members of the Black Press march in a renewed commitment to resilience, faith and preserving and uplifting African American history and culture.
“We have to keep publishing, we have to keep struggling, and we know that we will continue to make progress,” Chavis said. “God bless the Black Press of America.” WI


By Micha Green WI Managing Editor
This is certainly a time for shift, organization and action in the African American community, nation and world; but this moment is not completely unprecedented. We’ve been here before.
Yes, the president of the United States is attacking diversity, equity and inclusion (DEI), members of the press, and threatening to revoke funding for teaching aspects of Black history— often called critical race theory. Indeed, some GOP leaders have waged war against immigrants, the LBTQIA+ community, “wokeness,” and anything that seems to challenge the foundations of white supremacy. And, without a doubt, many Washingtonians are walking on pins and needles during this second Trump administration, worrying about federal job furloughs, funding for the District and legislative attempts to take away D.C.’s Home Rule.
For those like me, born into a fairly progressive time in the United States and growing up in the Washington, D.C. area — when it was truly “Chocolate City”— it seems like a wild, trying, divisive time.

But, having worked on the 60th anniversary special edition in great detail for the past few weeks, I can only imagine the challenges Dr. Calvin W. Rolark was facing when founding The Washington Informer, or what John B. Russworm and Samuel E. Cornish were battling when starting Freedom’s Journal in 1827.
Walking in the vision and legacy of Russworm and Cornish, I’ve always considered being a member of the Black Press as being a “freedom writer.” Though we’re journalists, and hope to tell stories truthfully and fairly, we also have a clear mission: uplifting African Americans and, truly all people, through our reporting that highlights the Black community.
Just as Russworm and Cornish wrote “We wish to plead our cause. Too long others have spoken for us,” 198 years ago in the first edition of Freedom’s Journal on March 16, 1827, Dr. Rolark also stated his reasoning for starting The Washington Informer in the publication’s premier issue on October 16, 1964.
“In this bi-racial city all citizens should develop a greater awareness of the Negro’s rich heritage and his important role in making ours a greater national capital,” Rolark wrote. “It is our hope through the pages of The Washington Informer to bring about better understanding between different ethnic
Please be a part of history and donate to our legacy.

5Washington Informer Managing Editor Micha Green is excited to continue the publication’s 60-year legacy of publishing positive stories that resist racism and uplifts the Black community. (WI File Photo/Anthony Tilghman)
groups through valid and wholesome activities and programs to achieve these purposes.”
Dr. Rolark’s words offer a glimpse into the challenges that the District, nation and Black community faced in 1964. He was clearly weary of negative news about Black Washingtonians, and ready to tell the story of what he called “the total community.”
The Informer’s founder hoped to highlight the beauty and breadth of the Black experience in D.C., in hopes for cross-cultural understanding, racial progress and true equity in the District and worldwide.
The Washington Informer, and Black Press in general, preserves Black history and narratives, all the while strengthening society.
It’s not simply about relaying news, but in doing so working toward global peace and justice.
“In the spirit of candor and humility we intend by a simple representation of facts to lay our case [for] the [public], with a view to arrest the progress of prejudice, and to shield ourselves against the consequent evils,” Russworm and Cornish wrote nearly two centuries ago.
What a powerful legacy Russworm, Cornish, Rolark and countless other Black publishers have created. Continuing their work is not only important, but critical in these times.
From the very beginning of the Black Press, the hope was that it would continue forever.
“We wish to conciliate all and to irritate none,” the Freedom’s Journal publishers wrote in their first edition, “yet we must be firm and unwavering in our principles, and persevering in our efforts.”
I’m excited to help further Rolark’s hopes and vision for The Washington Informer. Understanding his mission for positive news as a means to resist racism and hatred, propels me as managing editor.
His famous 10 words, “If it is to be, it is up to me,” remain a guiding light for the work necessary to effect positive change and progress.
The Washington Informer will continue telling stories of the local activists, entrepreneurs, politicians, educators, artists, athletes, faith leaders, young people, organizations, programs and changemakers doing work to strengthen the world.
Dr. Rolark saw the value in positive Black representation as a means of contributing to justice work. By publishing stories that showcase Black ingenuity and achievements, he was truly countering the negative narratives often reported in mainstream media.
That work is still necessary today.
In an age where DEI, Black history and speaking out against hate is weaponized, The Washington Informer will continue doing what it’s always done, resisting racism through uplifting storytelling, and combating misinformation by reporting facts and highlighting those who speak truth to power.
While not all stories are easy, sometimes having to cover tragedies, disparities, and tough battles, The Informer is always sure to feature the people who are working to address issues and improve circumstances.
Despite the Black community grappling with multiple inequities and challenges, it’s empowering to have 198 years of the Black Press to serve as a blueprint to help address today’s trials with fortitude and fearlessness.
The work will continue and only further, through The Washington Informer’s multiple platforms, which are ever-evolving. From the website, social media, WIN-TV and weekly print publication— where it all started— The Informer will forever publish work that furthers the goal of elevating and empowering Black communities and strengthening all people.
Through the highlights, like the historic election of President Barack Obama, to the lowlights, such as the police-involved murder of George Floyd captured on video in broad daylight, The Informer will keep telling all stories about the Black community.
In doing so, the publication ensures that Black voices, contributions and efforts will be persevered, and available to offer insight and inspiration for future generations.
Current challenges prove that maintaining peace and justice does not happen with isolated movements, but sustained dedication to work that promotes those values.
The Washington Informer will continue unapologetically highlighting Black stories, printing reliable facts, and dedicating its work to bettering the nation’s capital, country and world.
As a lover of catchphrases, I remain motivated by another one of Dr. Rolark’s famous sayings as we carry on his work and mission: “No one can save us, but us.”
Using his vision for The Informer as we look to the future, I’d like to add that no one can— or will— stop us.
In the spirit of the Black Press, The Washington Informer will continue to “plead our cause.” WI







Please be a part of history and donate to our legacy.












































































































































Congratulations to The Washington Informer on 60 years of impactful journalism and community service.
CareFirst BlueCross BlueShield is proud to celebrate this milestone with you. Your dedication to informing and uplifting our communities aligns perfectly with our mission to advance health and well-being across the region. Here’s to many more years of making a difference together.